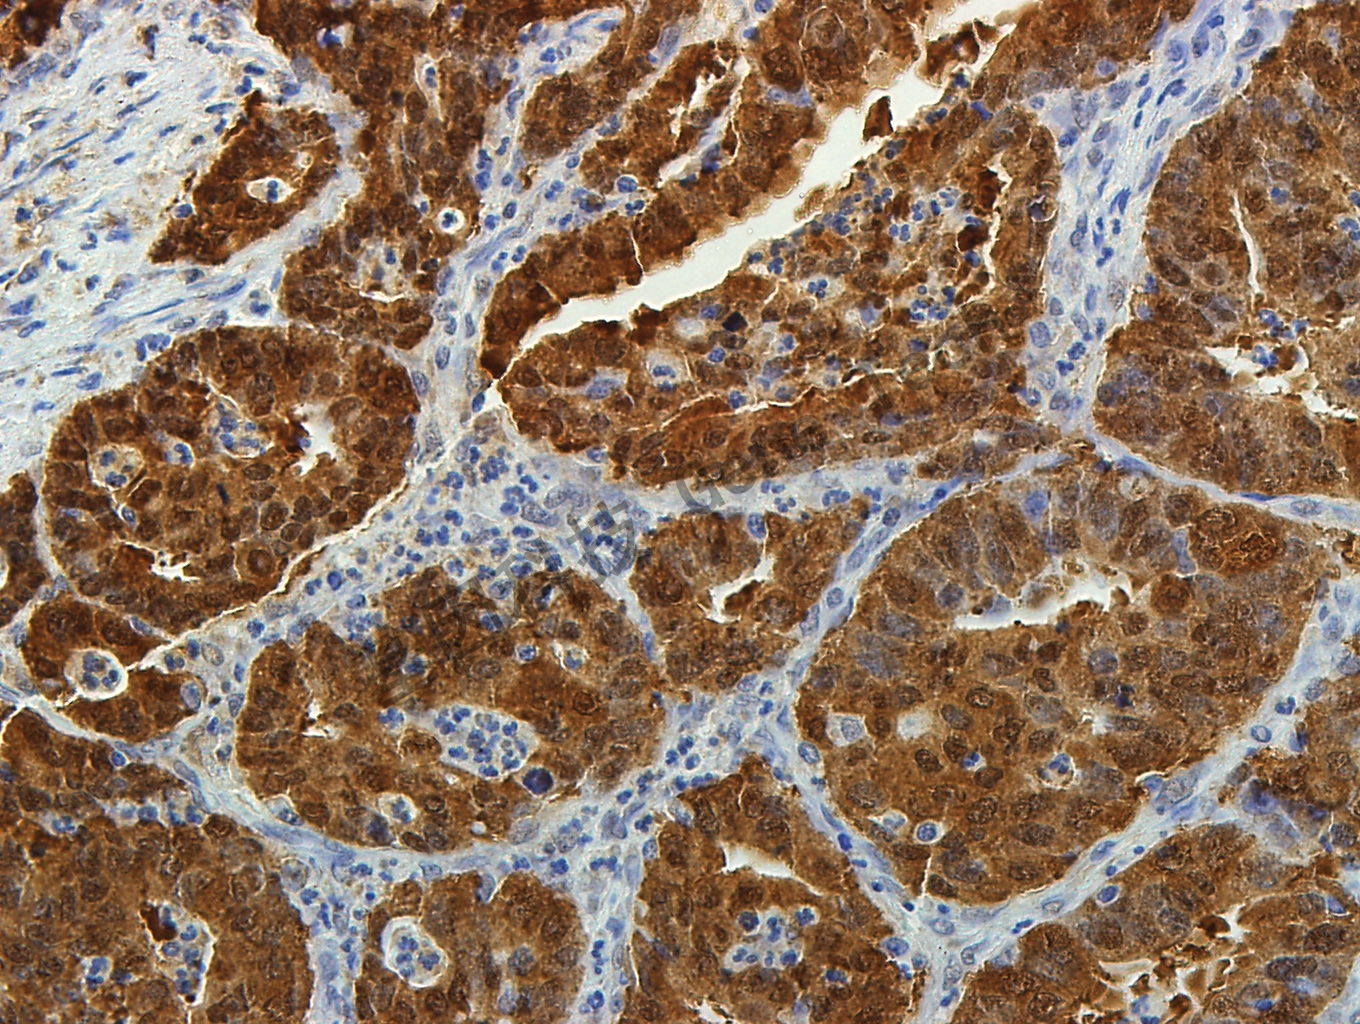
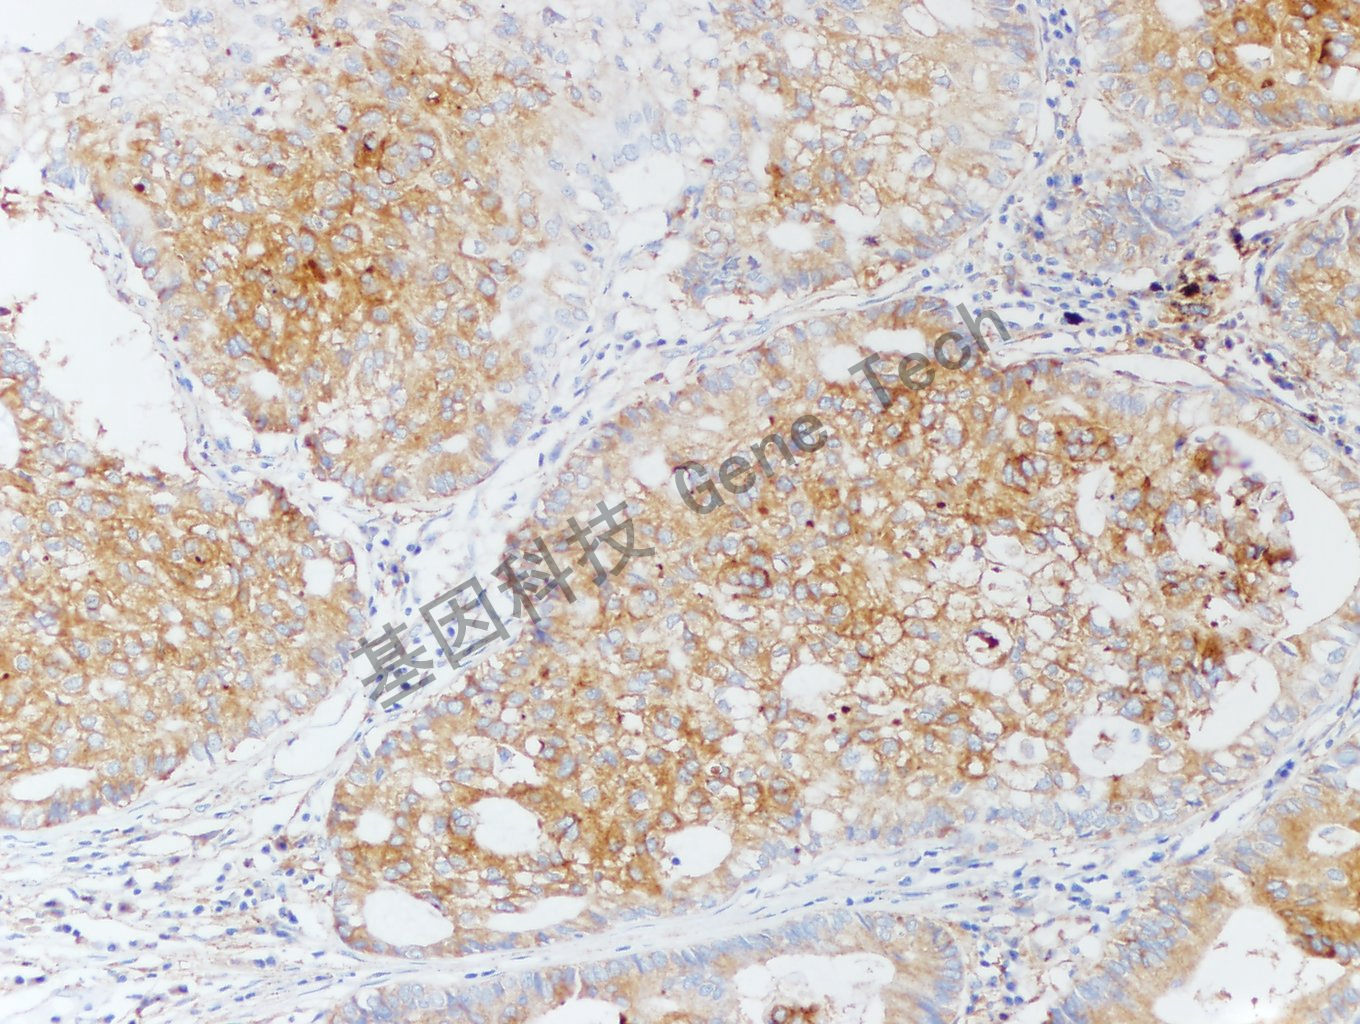
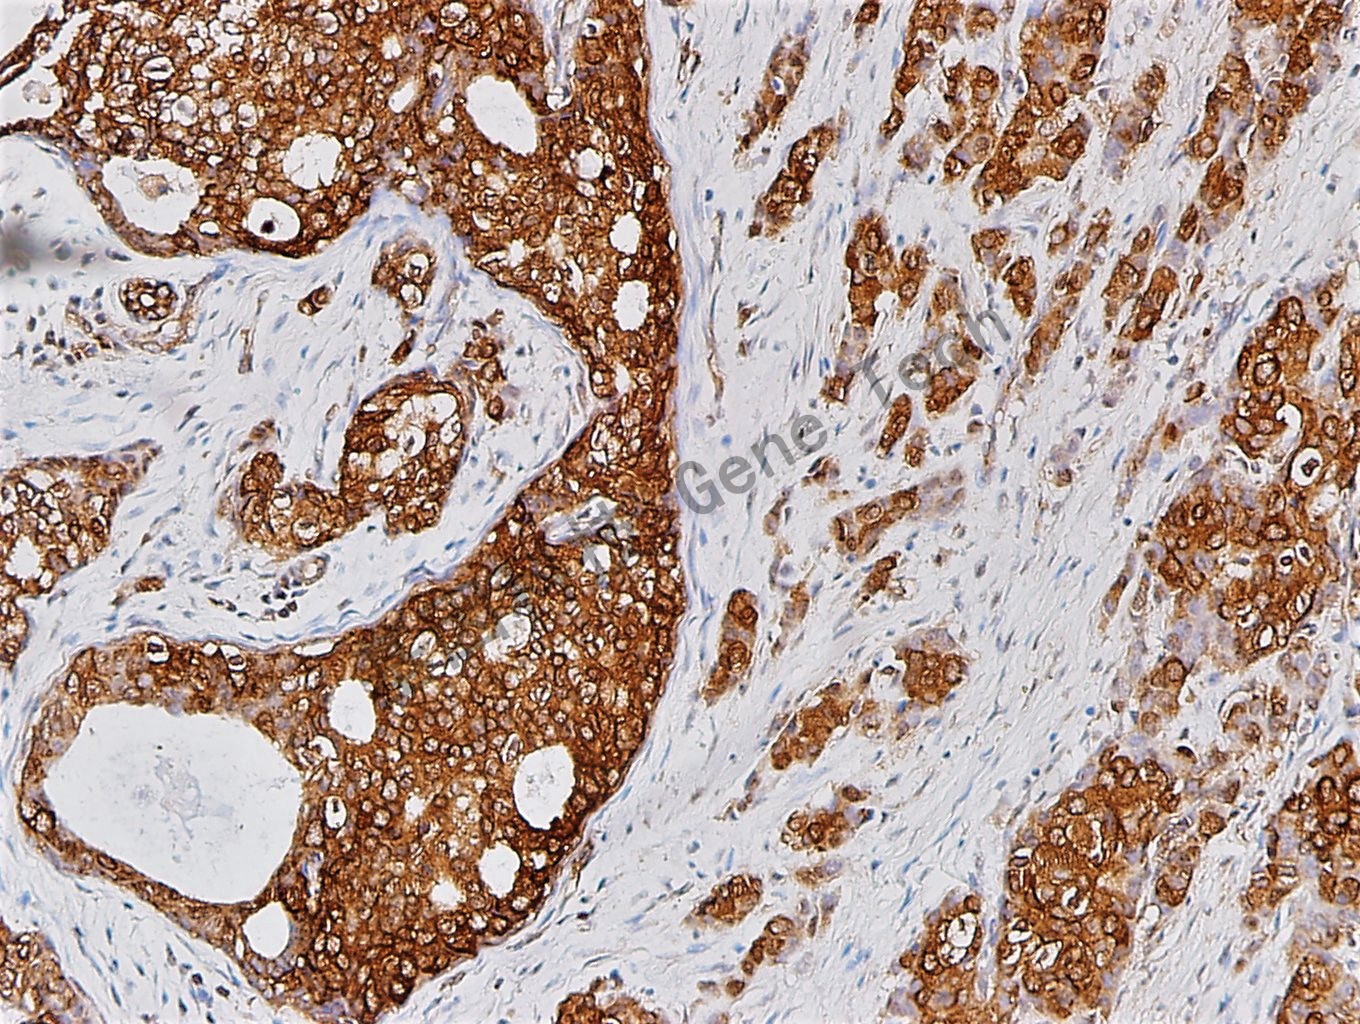
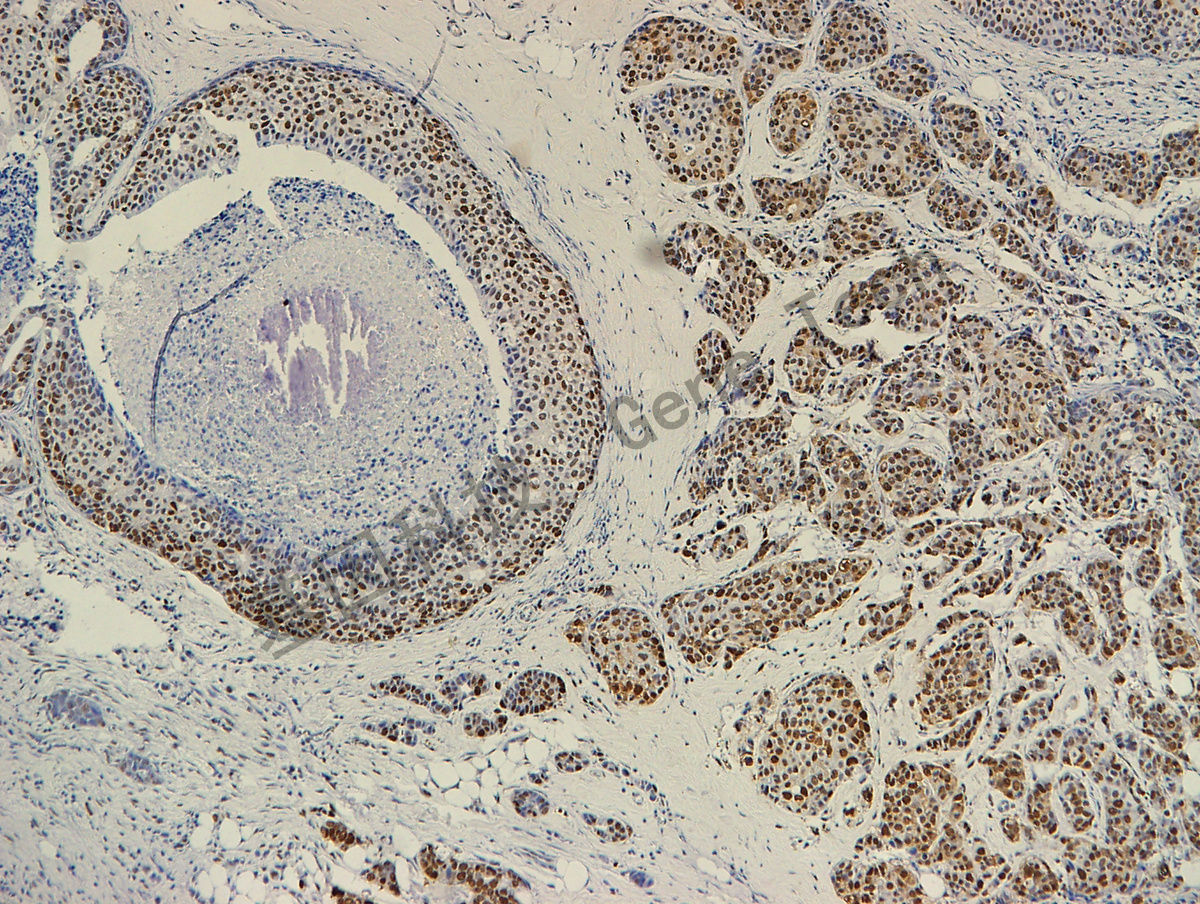

根据抗体首字母检索
-
![]() CDC73抗体试剂(免疫组织化学法)
货号:GT2611
克隆号:GR039
CDC73抗体试剂(免疫组织化学法)
货号:GT2611
克隆号:GR039
-
![]() CLDN18抗体检测试剂(免疫组织化学法)
货号:GT2542
克隆号:43-14A
CLDN18抗体检测试剂(免疫组织化学法)
货号:GT2542
克隆号:43-14A
-
![]() THY抗体试剂(免疫组织化学法)(TG)
货号:GT2619
克隆号:GR339
THY抗体试剂(免疫组织化学法)(TG)
货号:GT2619
克隆号:GR339
-
![]() 甲状腺转录因子-1 (TTF-1)抗体试剂(免疫组织化学)
货号:GM3575
克隆号:8G7G3/1
甲状腺转录因子-1 (TTF-1)抗体试剂(免疫组织化学)
货号:GM3575
克隆号:8G7G3/1
-
![]() CD138抗体试剂(免疫组织化学法)
货号:GT2617
克隆号:GM118
CD138抗体试剂(免疫组织化学法)
货号:GT2617
克隆号:GM118
-
![]() 细胞角蛋白(低分子量)抗体试剂(免疫组织化学)
货号:GT2246
克隆号:35βH11
细胞角蛋白(低分子量)抗体试剂(免疫组织化学)
货号:GT2246
克隆号:35βH11
-
![]() GPNMB抗体试剂(免疫组织化学法)
货号:GT2610
克隆号:GR537
GPNMB抗体试剂(免疫组织化学法)
货号:GT2610
克隆号:GR537
-
HMGA2 货号:GT2613 克隆号:D1A7
-
![]() IDH2抗体试剂(免疫组织化学法)
货号:GT2575
克隆号:GR335
IDH2抗体试剂(免疫组织化学法)
货号:GT2575
克隆号:GR335
-
![]() MEF2B抗体试剂(免疫组织化学法)
货号:GT2605
克隆号:GR041
MEF2B抗体试剂(免疫组织化学法)
货号:GT2605
克隆号:GR041
-
![]() MTAP抗体试剂(免疫组织化学法)
货号:GT2603
克隆号:GR536
MTAP抗体试剂(免疫组织化学法)
货号:GT2603
克隆号:GR536
-
![]() SPARC
货号:GT2607
克隆号:GR336
SPARC
货号:GT2607
克隆号:GR336
-
![]() HEG1
货号:GT2609
克隆号:GM117
HEG1
货号:GT2609
克隆号:GM117
-
![]() BCL-2抗体试剂(免疫组织化学法)
货号:GT2491
克隆号:GM325
BCL-2抗体试剂(免疫组织化学法)
货号:GT2491
克隆号:GM325
-
![]() CD56抗体试剂(免疫组织化学)
货号:GT2530
克隆号:GM109
CD56抗体试剂(免疫组织化学)
货号:GT2530
克隆号:GM109
-
![]() CD68抗体试剂(免疫组织化学)
货号:GM0876
克隆号:GM511
CD68抗体试剂(免疫组织化学)
货号:GM0876
克隆号:GM511
-
![]() 人疱疹病毒8型(HHV-8)抗体试剂(免疫组织化学法)
货号:GT2471
克隆号:13B10
人疱疹病毒8型(HHV-8)抗体试剂(免疫组织化学法)
货号:GT2471
克隆号:13B10
-
![]() 淀粉样蛋白A抗体试剂(免疫组织化学法)
货号:GT2473
克隆号:EP11592-92
淀粉样蛋白A抗体试剂(免疫组织化学法)
货号:GT2473
克隆号:EP11592-92
-
![]() 细胞角蛋白4(CK4)抗体试剂(免疫组织化学法)
货号:GT2472
克隆号:GR331
细胞角蛋白4(CK4)抗体试剂(免疫组织化学法)
货号:GT2472
克隆号:GR331
-
![]() 末端脱氧核苷酸转移酶(TdT)抗体试剂(免疫组织化学法)
货号:GT2529
克隆号:GR035
末端脱氧核苷酸转移酶(TdT)抗体试剂(免疫组织化学法)
货号:GT2529
克隆号:GR035
-
![]() 细胞周期蛋白B3(Cyclin B3,CCNB3)抗体试剂(免疫组织化学法)
货号:GT2570
克隆号:poly
细胞周期蛋白B3(Cyclin B3,CCNB3)抗体试剂(免疫组织化学法)
货号:GT2570
克隆号:poly
-
![]() 天冬氨酸蛋白酶(Napsin A)抗体试剂(免疫组织化学)
货号:GT2340
克隆号:GR302
天冬氨酸蛋白酶(Napsin A)抗体试剂(免疫组织化学)
货号:GT2340
克隆号:GR302
-
![]() Synaptophysin抗体试剂(免疫组织化学)
货号:GT2534
克隆号:GR306
Synaptophysin抗体试剂(免疫组织化学)
货号:GT2534
克隆号:GR306
-
![]() Nectin-4
货号:GT2558
克隆号:EPR15613-68
Nectin-4
货号:GT2558
克隆号:EPR15613-68
-
![]() H3.3G34R抗体试剂(免疫组织化学法)
货号:GT2553
克隆号:RM240
H3.3G34R抗体试剂(免疫组织化学法)
货号:GT2553
克隆号:RM240
-
![]() EBER probe(ISH method) EBER探针(原位杂交法)
货号:GK7300
EBER probe(ISH method) EBER探针(原位杂交法)
货号:GK7300
-
![]() EBER probe(ISH method) EBER探针(原位杂交法)三组分,GAS版
货号:GK7301
EBER probe(ISH method) EBER探针(原位杂交法)三组分,GAS版
货号:GK7301
-
![]() uPAR抗体试剂(免疫组织化学法)
货号:GT2408
克隆号:GR532
uPAR抗体试剂(免疫组织化学法)
货号:GT2408
克隆号:GR532
-
![]() δ样蛋白3(DLL3)抗体试剂(免疫组织化学法)
货号:GT2517
克隆号:EPR22592-18
δ样蛋白3(DLL3)抗体试剂(免疫组织化学法)
货号:GT2517
克隆号:EPR22592-18
-
![]() STAT3抗体试剂(免疫组织化学法)
货号:GT2494
克隆号:124H6
STAT3抗体试剂(免疫组织化学法)
货号:GT2494
克隆号:124H6
-
![]() IDO1 兔抗人 IDO1 抗体试剂(免疫组织化学法)
货号:GT2296
克隆号:GR528
IDO1 兔抗人 IDO1 抗体试剂(免疫组织化学法)
货号:GT2296
克隆号:GR528
-
![]() GAD2 鼠抗人 谷氨酸脱羧酶2(GAD2) 抗体试剂(免疫组织化学法)
货号:GT2597
克隆号:MSVA-602M
GAD2 鼠抗人 谷氨酸脱羧酶2(GAD2) 抗体试剂(免疫组织化学法)
货号:GT2597
克隆号:MSVA-602M
-
![]() DUX4 鼠抗人 DUX4 抗体试剂(免疫组织化学法)
货号:GT2596
克隆号:P4H2
DUX4 鼠抗人 DUX4 抗体试剂(免疫组织化学法)
货号:GT2596
克隆号:P4H2
-
![]() Prostein 兔抗人 前列腺癌相关蛋白P501S(P501S)抗体试剂(免疫组织化学法)
货号:GT2514
克隆号:ZR9
Prostein 兔抗人 前列腺癌相关蛋白P501S(P501S)抗体试剂(免疫组织化学法)
货号:GT2514
克隆号:ZR9
-
![]() 补体C4d抗体试剂(免疫组织化学法)
货号:GT2599
克隆号:GR527
补体C4d抗体试剂(免疫组织化学法)
货号:GT2599
克隆号:GR527
-
![]() JAM-A 兔抗人 连接黏附分子A(JAM-A)抗体试剂(免疫组织化学法)
货号:GT2598
克隆号:E8D2N
JAM-A 兔抗人 连接黏附分子A(JAM-A)抗体试剂(免疫组织化学法)
货号:GT2598
克隆号:E8D2N
-
![]() CD27抗体试剂(免疫组织化学法)
货号:GT2476
克隆号:GR115
CD27抗体试剂(免疫组织化学法)
货号:GT2476
克隆号:GR115
-
![]() FCRL4(IRTA1)抗体试剂(免疫组织化学法)
货号:GT260402
克隆号:GR114
FCRL4(IRTA1)抗体试剂(免疫组织化学法)
货号:GT260402
克隆号:GR114
-
![]() HER3 兔抗人 HER3 抗体试剂(免疫组织化学法)
货号:GT2417
克隆号:GR525
HER3 兔抗人 HER3 抗体试剂(免疫组织化学法)
货号:GT2417
克隆号:GR525
-
![]() Osterix 兔抗人 Osterix 抗体试剂(免疫组织化学法)
货号:GT2592
克隆号:EPR21034
Osterix 兔抗人 Osterix 抗体试剂(免疫组织化学法)
货号:GT2592
克隆号:EPR21034
-
![]() ARID1B
货号:GT2591
克隆号:EPR25408-34
ARID1B
货号:GT2591
克隆号:EPR25408-34
-
![]() PLA2R 兔抗人 PLA2R 抗体试剂(免疫组织化学法)
货号:GT2590
克隆号:EPR20483
PLA2R 兔抗人 PLA2R 抗体试剂(免疫组织化学法)
货号:GT2590
克隆号:EPR20483
-
![]() PROX1 兔抗人 Prospero相关同源异形盒蛋白1(PROX1) 抗体试剂(免疫组织化学法)
货号:GT2589
克隆号:EPR19273
PROX1 兔抗人 Prospero相关同源异形盒蛋白1(PROX1) 抗体试剂(免疫组织化学法)
货号:GT2589
克隆号:EPR19273
-
![]() ROS1抗体试剂(免疫组织化学法)
货号:GT2546
克隆号:EPMGHR2
ROS1抗体试剂(免疫组织化学法)
货号:GT2546
克隆号:EPMGHR2
-
![]() EPM2AIP1 鼠抗人 EPM2A相互作用蛋白1(EPM2AIP1)抗体试剂(免疫组织化学法)
货号:GT2545
克隆号:GM012
EPM2AIP1 鼠抗人 EPM2A相互作用蛋白1(EPM2AIP1)抗体试剂(免疫组织化学法)
货号:GT2545
克隆号:GM012
-
![]() TFEB 兔抗人 TFEB 抗体试剂(免疫组织化学法)
货号:GT2537
克隆号:EPR22940-151
TFEB 兔抗人 TFEB 抗体试剂(免疫组织化学法)
货号:GT2537
克隆号:EPR22940-151
-
![]() PAX-7 鼠抗人 PAX-7 抗体试剂(免疫组织化学法)
货号:GT2518
克隆号:PAX7/1187
PAX-7 鼠抗人 PAX-7 抗体试剂(免疫组织化学法)
货号:GT2518
克隆号:PAX7/1187
-
![]() 原癌基因蛋白N(n-Myc)抗体试剂(免疫组织化学法)
货号:GT2601
克隆号:D4B2Y
原癌基因蛋白N(n-Myc)抗体试剂(免疫组织化学法)
货号:GT2601
克隆号:D4B2Y
-
![]() BTLA抗体试剂(免疫组织化学法)
货号:GT2406
克隆号:EPR22224-271
BTLA抗体试剂(免疫组织化学法)
货号:GT2406
克隆号:EPR22224-271
-
![]() FHIT 兔抗人 FHIT 抗体试剂(免疫组织化学法)
货号:GT2477
克隆号:GR523
FHIT 兔抗人 FHIT 抗体试剂(免疫组织化学法)
货号:GT2477
克隆号:GR523
-
![]() S100A1
货号:GT2555
克隆号:EPR19013
S100A1
货号:GT2555
克隆号:EPR19013
-
![]() PRKAR1A 兔抗人 PRKAR1A
货号:GT2582
克隆号:poly
PRKAR1A 兔抗人 PRKAR1A
货号:GT2582
克隆号:poly
-
![]() Dysferlin
货号:GT2581
克隆号:GR522
Dysferlin
货号:GT2581
克隆号:GR522
-
![]() POU2F3抗体试剂(免疫组织化学法)
货号:GT2580
克隆号:GR043
POU2F3抗体试剂(免疫组织化学法)
货号:GT2580
克隆号:GR043
-
![]() CYP11B1 兔抗人 CYP11B1 抗体试剂 (免疫组织化学法)
货号:GT2583
克隆号:poly
CYP11B1 兔抗人 CYP11B1 抗体试剂 (免疫组织化学法)
货号:GT2583
克隆号:poly
-
![]() 雄激素受体剪切变异体7(AR-V7)抗体试剂(免疫组织化学法)
货号:GT2576
克隆号:EPR15656
雄激素受体剪切变异体7(AR-V7)抗体试剂(免疫组织化学法)
货号:GT2576
克隆号:EPR15656
-
![]() CD47抗体试剂(免疫组织化学法)
货号:GT2501
克隆号:GR112
CD47抗体试剂(免疫组织化学法)
货号:GT2501
克隆号:GR112
-
![]() CD117抗体试剂(免疫组织化学法)
货号:GT2579
克隆号:GR521
CD117抗体试剂(免疫组织化学法)
货号:GT2579
克隆号:GR521
-
![]() HIK1083抗体试剂(免疫组织化学法)
货号:GT2521
克隆号:HIK1083
HIK1083抗体试剂(免疫组织化学法)
货号:GT2521
克隆号:HIK1083
-
![]() CYP17A1 鼠抗人 CYP17A1 抗体试剂(免疫组织化学法)
货号:GT2578
克隆号:GM315
CYP17A1 鼠抗人 CYP17A1 抗体试剂(免疫组织化学法)
货号:GT2578
克隆号:GM315
-
![]() CDK12 兔抗人 CDK12 抗体试剂(免疫组织化学)
货号:GT2577
克隆号:GR023
CDK12 兔抗人 CDK12 抗体试剂(免疫组织化学)
货号:GT2577
克隆号:GR023
-
![]() CTLA4 兔抗人 CTLA4 抗体试剂(免疫组织化学法)
货号:GT2573
克隆号:GR520
CTLA4 兔抗人 CTLA4 抗体试剂(免疫组织化学法)
货号:GT2573
克隆号:GR520
-
![]() p62 兔抗人 p62 抗体试剂(免疫组织化学)
货号:GT2557
克隆号:EPR18351
p62 兔抗人 p62 抗体试剂(免疫组织化学)
货号:GT2557
克隆号:EPR18351
-
![]() DDIT3 鼠抗人 DDIT3 抗体试剂(免疫组织化学)
货号:GT2551
克隆号:9C8
DDIT3 鼠抗人 DDIT3 抗体试剂(免疫组织化学)
货号:GT2551
克隆号:9C8
-
![]() CYP11B2 兔抗人 CYP11B2 抗体试剂(免疫组织化学法)
货号:GT2569
克隆号:EPR10494
CYP11B2 兔抗人 CYP11B2 抗体试剂(免疫组织化学法)
货号:GT2569
克隆号:EPR10494
-
![]() CRP抗体试剂(免疫组织化学法)
货号:GT2568
克隆号:GR020
CRP抗体试剂(免疫组织化学法)
货号:GT2568
克隆号:GR020
-
![]() BAP1抗体试剂(免疫组织化学法)
货号:GT2567
克隆号:C-4
BAP1抗体试剂(免疫组织化学法)
货号:GT2567
克隆号:C-4
-
![]() 双肾上腺皮质激素样激酶1(DCLK1)抗体试剂(免疫组织化学法)
货号:GT2565
克隆号:GR519
双肾上腺皮质激素样激酶1(DCLK1)抗体试剂(免疫组织化学法)
货号:GT2565
克隆号:GR519
-
![]() FOXC1 兔抗人 FOXC1 抗体试剂(免疫组织化学法)
货号:GT2564
克隆号:GR021
FOXC1 兔抗人 FOXC1 抗体试剂(免疫组织化学法)
货号:GT2564
克隆号:GR021
-
![]() AKR1B10抗体试剂(免疫组织化学法)
货号:GT2563
克隆号:EPR14421
AKR1B10抗体试剂(免疫组织化学法)
货号:GT2563
克隆号:EPR14421
-
![]() NR4A3抗体试剂(免疫组织化学法)
货号:GT2522
克隆号:GR040
NR4A3抗体试剂(免疫组织化学法)
货号:GT2522
克隆号:GR040
-
![]() CK6 兔抗人 细胞角蛋白 6(CK6)抗体试剂(免疫组织化学法)
货号:GT2490
克隆号:GR316
CK6 兔抗人 细胞角蛋白 6(CK6)抗体试剂(免疫组织化学法)
货号:GT2490
克隆号:GR316
-
Chymotrypsin 兔抗人 Chymotrypsin 抗体试剂(免疫组织化学) 货号:GT2559 克隆号:poly
-
HSA抗体试剂(免疫组织化学法)(荧光抗体) 货号:GF0214 克隆号:poly
-
![]() MTDH/AEG1 兔抗人 易粘蛋白(MTDH)抗体试剂(免疫组织化学法)
货号:GT2415
克隆号:EPR20797
MTDH/AEG1 兔抗人 易粘蛋白(MTDH)抗体试剂(免疫组织化学法)
货号:GT2415
克隆号:EPR20797
-
![]() Iba1 兔抗人 同种异体移植炎症因子1(AIF1)抗体试剂(免疫组织化学法)
货号:GT2500
克隆号:GR516
Iba1 兔抗人 同种异体移植炎症因子1(AIF1)抗体试剂(免疫组织化学法)
货号:GT2500
克隆号:GR516
-
![]() SS18-SSX 兔抗人 SS18-SSX 抗体试剂(免疫组织化学法)
货号:GT2561
克隆号:E9X9V
SS18-SSX 兔抗人 SS18-SSX 抗体试剂(免疫组织化学法)
货号:GT2561
克隆号:E9X9V
-
![]() gamma Sarcoglycan 兔抗人 γ-肌聚糖蛋白(Gamma Sarcoglycan)抗体试剂(免疫组织化学法)
货号:GT2511
克隆号:GR517
gamma Sarcoglycan 兔抗人 γ-肌聚糖蛋白(Gamma Sarcoglycan)抗体试剂(免疫组织化学法)
货号:GT2511
克隆号:GR517
-
![]() Myosin Light Chain 2 兔抗人 肌球蛋白轻链2(Myosin Light Chain2)抗体试剂(免疫组织化学法)
货号:GT2496
克隆号:GR315
Myosin Light Chain 2 兔抗人 肌球蛋白轻链2(Myosin Light Chain2)抗体试剂(免疫组织化学法)
货号:GT2496
克隆号:GR315
-
![]() STING 兔抗人 STING 抗体试剂(免疫组织化学法)
货号:GT2493
克隆号:GR514
STING 兔抗人 STING 抗体试剂(免疫组织化学法)
货号:GT2493
克隆号:GR514
-
![]() 2SC抗体试剂(免疫组织化学法)
货号:GT2544
克隆号:poly
2SC抗体试剂(免疫组织化学法)
货号:GT2544
克隆号:poly
-
![]() SSTR5 兔抗人 SSTR5 抗体试剂(免疫组织化学法)
货号:GT2552
克隆号:UMB4
SSTR5 兔抗人 SSTR5 抗体试剂(免疫组织化学法)
货号:GT2552
克隆号:UMB4
-
![]() Trypsin 兔抗人 Trypsin 抗体试剂(免疫组织化学)
货号:GT2549
克隆号:EPR19498-43
Trypsin 兔抗人 Trypsin 抗体试剂(免疫组织化学)
货号:GT2549
克隆号:EPR19498-43
-
![]() MNDA抗体试剂(免疫组织化学法)
货号:GT2550
克隆号:253A
MNDA抗体试剂(免疫组织化学法)
货号:GT2550
克隆号:253A
-
![]() Clusterin 兔抗人 Clusterin 抗体试剂(免疫组织化学法)
货号:GT2548
克隆号:GR313
Clusterin 兔抗人 Clusterin 抗体试剂(免疫组织化学法)
货号:GT2548
克隆号:GR313
-
![]() CD79b 兔抗人 CD79b 抗体试剂(免疫组织化学法)
货号:GT2536
克隆号:EPR6861
CD79b 兔抗人 CD79b 抗体试剂(免疫组织化学法)
货号:GT2536
克隆号:EPR6861
-
![]() 组织蛋白酶K(CathepsinK)抗体试剂(免疫组织化学法)
货号:GT2547
克隆号:EPR19992
组织蛋白酶K(CathepsinK)抗体试剂(免疫组织化学法)
货号:GT2547
克隆号:EPR19992
-
![]() H+/K+ATPase β 鼠抗人 H+/K+-ATP酶β抗体试剂(免疫组织化学法)(ATP4B)
货号:GT2541
克隆号:C-4
H+/K+ATPase β 鼠抗人 H+/K+-ATP酶β抗体试剂(免疫组织化学法)(ATP4B)
货号:GT2541
克隆号:C-4
-
![]() CD11b抗体试剂(免疫组织化学法)
货号:GT2543
克隆号:GM112
CD11b抗体试剂(免疫组织化学法)
货号:GT2543
克隆号:GM112
-
![]() YAP1 兔抗人 YAP1 抗体试剂(免疫组织化学法)
货号:GT2540
克隆号:GR513
YAP1 兔抗人 YAP1 抗体试剂(免疫组织化学法)
货号:GT2540
克隆号:GR513
-
![]() 转录抑制因子GATA结合基因1(TRPS1) 抗体试剂(免疫组织化学法)
货号:GT2554
克隆号:GR018
转录抑制因子GATA结合基因1(TRPS1) 抗体试剂(免疫组织化学法)
货号:GT2554
克隆号:GR018
-
![]() SMARCE1 兔抗人 SMARCE1 抗体试剂(免疫组织化学法)
货号:GT2538
克隆号:EPR8848
SMARCE1 兔抗人 SMARCE1 抗体试剂(免疫组织化学法)
货号:GT2538
克隆号:EPR8848
-
![]() PU.1 兔抗人 PU.1 抗体试剂(免疫组织化学法)
货号:GT2495
克隆号:GR019
PU.1 兔抗人 PU.1 抗体试剂(免疫组织化学法)
货号:GT2495
克隆号:GR019
-
![]() PBRM1 兔抗人 PBRM1 抗体试剂(免疫组织化学法)
货号:GT2539
克隆号:GR017
PBRM1 兔抗人 PBRM1 抗体试剂(免疫组织化学法)
货号:GT2539
克隆号:GR017
-
![]() c-Myb 兔抗人 MYB 抗体试剂(免疫组织化学法)
货号:GT2480
克隆号:poly
c-Myb 兔抗人 MYB 抗体试剂(免疫组织化学法)
货号:GT2480
克隆号:poly
-
![]() VIP 兔抗人 血管活性肠多肽(VIP)抗体试剂
货号:GT2489
克隆号:poly
VIP 兔抗人 血管活性肠多肽(VIP)抗体试剂
货号:GT2489
克隆号:poly
-
![]() SDHA 兔抗人 琥珀酸脱氢酶A亚基(SDHA)抗体试剂(免疫组织化学法)
货号:GT2436
克隆号:GR300
SDHA 兔抗人 琥珀酸脱氢酶A亚基(SDHA)抗体试剂(免疫组织化学法)
货号:GT2436
克隆号:GR300
-
![]() FOXL2 兔抗人 FOXL2 抗体试剂(免疫组织化学法)
货号:GT2535
克隆号:EPR23523-68
FOXL2 兔抗人 FOXL2 抗体试剂(免疫组织化学法)
货号:GT2535
克隆号:EPR23523-68
-
![]() E-Cadherin 鼠抗人 E-Cadherin 抗体试剂(免疫组织化学)
货号:GT2348
克隆号:GM108
E-Cadherin 鼠抗人 E-Cadherin 抗体试剂(免疫组织化学)
货号:GT2348
克隆号:GM108
-
![]() BG8,Lewisy抗体试剂(免疫组织化学法)
货号:GT2502
克隆号:GM507
BG8,Lewisy抗体试剂(免疫组织化学法)
货号:GT2502
克隆号:GM507
-
![]() CD200抗体试剂(免疫组织化学法)
货号:GT2478
克隆号:EPR22412-229
CD200抗体试剂(免疫组织化学法)
货号:GT2478
克隆号:EPR22412-229
-
![]() DAXX 兔抗人 Daxx 抗体试剂(免疫组织化学法)
货号:GT2527
克隆号:GR510
DAXX 兔抗人 Daxx 抗体试剂(免疫组织化学法)
货号:GT2527
克隆号:GR510
-
![]() FOXP3抗体试剂(免疫组织化学法)
货号:GT2464
克隆号:GR037
FOXP3抗体试剂(免疫组织化学法)
货号:GT2464
克隆号:GR037
-
![]() ICOS 兔抗人 ICOS 抗体试剂(免疫组织化学法)
货号:GT2492
克隆号:SP98
ICOS 兔抗人 ICOS 抗体试剂(免疫组织化学法)
货号:GT2492
克隆号:SP98
-
IgG1抗体试剂(免疫组织化学法)(荧光抗体) 货号:GF0208 克隆号:4E3
-
IgG2抗体试剂(免疫组织化学法)(荧光抗体) 货号:GF0209 克隆号:HP-6014
-
IgG3抗体试剂(免疫组织化学法)(荧光抗体) 货号:GF0210 克隆号:HP-6050
-
IgG4抗体试剂(免疫组织化学)(荧光抗体) 货号:GF0211 克隆号:GF0211
-
![]() p40 兔抗人 p40 抗体试剂(免疫组织化学)
货号:GT2531
克隆号:GM008
p40 兔抗人 p40 抗体试剂(免疫组织化学)
货号:GT2531
克隆号:GM008
-
![]() SMARCA2 兔抗人 SMARCA2(BRM) 抗体试剂(免疫组织化学法)
货号:GT2524
克隆号:GR509
SMARCA2 兔抗人 SMARCA2(BRM) 抗体试剂(免疫组织化学法)
货号:GT2524
克隆号:GR509
-
![]() TPO 鼠抗人TPO 抗体试剂(免疫组织化学)
货号:GT2167
克隆号:AC25
TPO 鼠抗人TPO 抗体试剂(免疫组织化学)
货号:GT2167
克隆号:AC25
-
![]() WT1抗体试剂(免疫组织化学)
货号:GT2450
克隆号:EP122
WT1抗体试剂(免疫组织化学)
货号:GT2450
克隆号:EP122
-
![]() p63 鼠抗人 p63 抗体试剂(免疫组织化学)
货号:GT2532
克隆号:GM009
p63 鼠抗人 p63 抗体试剂(免疫组织化学)
货号:GT2532
克隆号:GM009
-
![]() AnnexinA1抗体试剂(免疫组织化学)
货号:GT2486
克隆号:poly
AnnexinA1抗体试剂(免疫组织化学)
货号:GT2486
克隆号:poly
-
![]() NKX6.1 兔抗人 NKX6.1 抗体试剂(免疫组织化学法)
货号:GT2520
克隆号:EPR20405
NKX6.1 兔抗人 NKX6.1 抗体试剂(免疫组织化学法)
货号:GT2520
克隆号:EPR20405
-
![]() 神经细胞分化因子1(NeuroD1) 抗体试剂(免疫组织化学法)
货号:GT2475
克隆号:EPR20766
神经细胞分化因子1(NeuroD1) 抗体试剂(免疫组织化学法)
货号:GT2475
克隆号:EPR20766
-
![]() LAG-3 兔抗人 LAG-3 抗体试剂(免疫组织化学法)
货号:GT2528
克隆号:GR109
LAG-3 兔抗人 LAG-3 抗体试剂(免疫组织化学法)
货号:GT2528
克隆号:GR109
-
![]() HSP27 兔抗人 热休克蛋白27(HSP27)抗体试剂(免疫组织化学法)
货号:GT2479
克隆号:GR507
HSP27 兔抗人 热休克蛋白27(HSP27)抗体试剂(免疫组织化学法)
货号:GT2479
克隆号:GR507
-
![]() GAP43 兔抗人 GAP43 抗体试剂(免疫组织化学法)
货号:GT2498
克隆号:GR508
GAP43 兔抗人 GAP43 抗体试剂(免疫组织化学法)
货号:GT2498
克隆号:GR508
-
![]() 窖蛋白-1(Caveolin-1)抗体试剂(免疫组织化学法)
货号:GT2344
克隆号:GR108
窖蛋白-1(Caveolin-1)抗体试剂(免疫组织化学法)
货号:GT2344
克隆号:GR108
-
![]() BCOR抗体试剂(免疫组织化学)
货号:GT2469
克隆号:C-10
BCOR抗体试剂(免疫组织化学)
货号:GT2469
克隆号:C-10
-
![]() BCL-10抗体试剂(免疫组织化学法)
货号:GT2133
克隆号:331.3
BCL-10抗体试剂(免疫组织化学法)
货号:GT2133
克隆号:331.3
-
![]() ARID1A抗体试剂(免疫组织化学法)
货号:GT2519
克隆号:GR014
ARID1A抗体试剂(免疫组织化学法)
货号:GT2519
克隆号:GR014
-
![]() TIM3 兔抗人 TIM3 抗体试剂(免疫组织化学法)
货号:GT2510
克隆号:GR505
TIM3 兔抗人 TIM3 抗体试剂(免疫组织化学法)
货号:GT2510
克隆号:GR505
-
c-Met 兔抗人 C-MET 抗体试剂(免疫组织化学) 货号:GT2374 克隆号:GR524
-
![]() VISTA 兔抗人 T细胞活化的V结构域Ig抑制因子(VISTA)抗体试剂(免疫组织化学法)
货号:GT2461
克隆号:SP345
VISTA 兔抗人 T细胞活化的V结构域Ig抑制因子(VISTA)抗体试剂(免疫组织化学法)
货号:GT2461
克隆号:SP345
-
![]() VEGFR3 鼠抗人 血管内皮生长因子受体3(VEGFR3)抗体试剂(免疫组织化学法)
货号:GT2424
克隆号:KLT9
VEGFR3 鼠抗人 血管内皮生长因子受体3(VEGFR3)抗体试剂(免疫组织化学法)
货号:GT2424
克隆号:KLT9
-
![]() VEGFR2 鼠抗人 血管内皮生长因子受体2(VEGFR2)抗体试剂(免疫组织化学法)
货号:GT2361
克隆号:D-8
VEGFR2 鼠抗人 血管内皮生长因子受体2(VEGFR2)抗体试剂(免疫组织化学法)
货号:GT2361
克隆号:D-8
-
![]() TRIM29 鼠抗人 TRIM29 抗体试剂(免疫组织化学法)
货号:GT2422
克隆号:GM505
TRIM29 鼠抗人 TRIM29 抗体试剂(免疫组织化学法)
货号:GT2422
克隆号:GM505
-
![]() Tubulin β 鼠抗人 微管蛋白β(Tubulin-β)抗体试剂(免疫组织化学法)
Tubulin β 鼠抗人 微管蛋白β(Tubulin-β)抗体试剂(免疫组织化学法)
-
![]() 黑色素瘤优先表达抗原(PRAME)抗体试剂(免疫组织化学法)
货号:GT2466
克隆号:EPR20330
黑色素瘤优先表达抗原(PRAME)抗体试剂(免疫组织化学法)
货号:GT2466
克隆号:EPR20330
-
![]() SOX-9 兔抗人 SOX-9 抗体试剂(免疫组织化学法)
SOX-9 兔抗人 SOX-9 抗体试剂(免疫组织化学法)
-
![]() PD-L2 鼠抗人 程序性死亡配体2(PD-L2)抗体试剂(免疫组织化学法)
PD-L2 鼠抗人 程序性死亡配体2(PD-L2)抗体试剂(免疫组织化学法)
-
![]() Melanoma gp100 兔抗人Melanoma gp100
Melanoma gp100 兔抗人Melanoma gp100
-
![]() 髓样/组织细胞抗原(Myeloid/Histiocyte Antigen,MHA)抗体试剂(免疫组织化学法)
货号:GT2371
克隆号:MAC387
髓样/组织细胞抗原(Myeloid/Histiocyte Antigen,MHA)抗体试剂(免疫组织化学法)
货号:GT2371
克隆号:MAC387
-
![]() PDGFRα 兔抗人 血小板衍生生长因子受体α(PDGFRα)抗体试剂(免疫组织化学法)
PDGFRα 兔抗人 血小板衍生生长因子受体α(PDGFRα)抗体试剂(免疫组织化学法)
-
![]() MCC 鼠抗人 肥大细胞类凝乳蛋白酶(MCC)抗体试剂(免疫组织化学法)
MCC 鼠抗人 肥大细胞类凝乳蛋白酶(MCC)抗体试剂(免疫组织化学法)
-
![]() MAP 2a.b.c 鼠抗人 微管相关蛋白2a.b.c(MAP 2a.b.c)抗体试剂(免疫组织化学法)
MAP 2a.b.c 鼠抗人 微管相关蛋白2a.b.c(MAP 2a.b.c)抗体试剂(免疫组织化学法)
-
![]() LIN28 兔抗人 LIN28 抗体试剂(免疫组织化学法)
LIN28 兔抗人 LIN28 抗体试剂(免疫组织化学法)
-
![]() IgG1 鼠抗人 IgG1 抗体试剂(免疫组织化学法)
IgG1 鼠抗人 IgG1 抗体试剂(免疫组织化学法)
-
![]() HNF4α 兔抗人 HNF4α
HNF4α 兔抗人 HNF4α
-
![]() HPV16/18-E6 鼠抗人 人乳头瘤病毒16/18 E6 蛋白(HPV16/18-E6)抗体试剂(免疫组织化学法)
HPV16/18-E6 鼠抗人 人乳头瘤病毒16/18 E6 蛋白(HPV16/18-E6)抗体试剂(免疫组织化学法)
-
![]() Factor XIII A 兔抗人 Factor XIII A 抗体试剂(免疫组织化学法)
Factor XIII A 兔抗人 Factor XIII A 抗体试剂(免疫组织化学法)
-
![]() 连接蛋白43(Connexin 43,Cx43)抗体 兔抗人 Connexin 43
多克隆
连接蛋白43(Connexin 43,Cx43)抗体 兔抗人 Connexin 43
多克隆
-
![]() pan-TRK 兔抗人 抗广谱原肌球蛋白受体激酶 (TRK) 抗体试剂(免疫组织化学法)
pan-TRK 兔抗人 抗广谱原肌球蛋白受体激酶 (TRK) 抗体试剂(免疫组织化学法)
-
![]() PEG10 鼠抗人 PEG10 抗体试剂(免疫组织化学法)
PEG10 鼠抗人 PEG10 抗体试剂(免疫组织化学法)
-
![]() TROP2 兔抗人 滋养层细胞表面抗原2(TROP2)抗体试剂(免疫组织化学法)
TROP2 兔抗人 滋养层细胞表面抗原2(TROP2)抗体试剂(免疫组织化学法)
-
![]() INSM1 兔抗人 INSM1 抗体试剂(免疫组织化学法)
INSM1 兔抗人 INSM1 抗体试剂(免疫组织化学法)
-
![]() HLA-DR 兔抗人 HLA-DR 抗体试剂(免疫组织化学)
货号:GT2382
克隆号:GR515
HLA-DR 兔抗人 HLA-DR 抗体试剂(免疫组织化学)
货号:GT2382
克隆号:GR515
-
![]() CXCL-13 抗体 兔抗人 CXCL-13
多克隆
CXCL-13 抗体 兔抗人 CXCL-13
多克隆
-
![]() 转录抑制因子GATA结合基因1(TRPS1)抗体试剂(免疫组织化学法)
货号:GT2454
克隆号:EPR16171
转录抑制因子GATA结合基因1(TRPS1)抗体试剂(免疫组织化学法)
货号:GT2454
克隆号:EPR16171
-
![]() (停产)Caldesmon 鼠抗人 Caldesmon 抗体试剂(免疫组织化学)(h-CALD)
货号:GT2465
克隆号:h-CALD
(停产)Caldesmon 鼠抗人 Caldesmon 抗体试剂(免疫组织化学)(h-CALD)
货号:GT2465
克隆号:h-CALD
-
![]() APC 抗体试剂(免疫组织化学法)
货号:GT2392
克隆号:GR535
APC 抗体试剂(免疫组织化学法)
货号:GT2392
克隆号:GR535
-
![]() BRCA1抗体试剂(免疫组织化学法)
货号:GT2375
克隆号:EPR19433
BRCA1抗体试剂(免疫组织化学法)
货号:GT2375
克隆号:EPR19433
-
![]() Pepsinogen I 鼠抗人 胃蛋白酶原1(PepsinogenI)抗体试剂(免疫组织化学法)
货号:GT2463
克隆号:7G3
Pepsinogen I 鼠抗人 胃蛋白酶原1(PepsinogenI)抗体试剂(免疫组织化学法)
货号:GT2463
克隆号:7G3
-
![]() NUT 兔抗人 睾丸核蛋白(NUT)抗体试剂(免疫组织化学法)
NUT 兔抗人 睾丸核蛋白(NUT)抗体试剂(免疫组织化学法)
-
![]() S-100 A4 兔抗人 S100 钙结合蛋白A4(S-100 A4)抗体试剂(免疫组织化学法)
S-100 A4 兔抗人 S100 钙结合蛋白A4(S-100 A4)抗体试剂(免疫组织化学法)
-
![]() PHOX2B 兔抗人 PHOX2B 抗体试剂(免疫组织化学法)
货号:GT2455
克隆号:EPR14423
PHOX2B 兔抗人 PHOX2B 抗体试剂(免疫组织化学法)
货号:GT2455
克隆号:EPR14423
-
![]() NY-ESO-1 兔抗人 纽约食管鳞状细胞癌1(NY-ESO-1)抗体试剂(免疫组织化学法)
货号:GT2516
克隆号:EPR13780
NY-ESO-1 兔抗人 纽约食管鳞状细胞癌1(NY-ESO-1)抗体试剂(免疫组织化学法)
货号:GT2516
克隆号:EPR13780
-
![]() L1CAM 兔抗人 L1-细胞粘附分子(L1CAM) 抗体试剂(免疫组织化学法)
L1CAM 兔抗人 L1-细胞粘附分子(L1CAM) 抗体试剂(免疫组织化学法)
-
![]() IgG2 兔抗人 IgG2 抗体试剂(免疫组织化学法)
IgG2 兔抗人 IgG2 抗体试剂(免疫组织化学法)
-
![]() HE4 鼠抗人 人附睾蛋白4(HE4)抗体试剂(免疫组织化学法)
HE4 鼠抗人 人附睾蛋白4(HE4)抗体试剂(免疫组织化学法)
-
![]() DPC4 兔抗人 DPC4 抗体试剂(免疫组织化学法)
DPC4 兔抗人 DPC4 抗体试剂(免疫组织化学法)
-
![]() AMACR/p504s抗体试剂(免疫组织化学)
货号:GT2453
克隆号:GM305
AMACR/p504s抗体试剂(免疫组织化学)
货号:GT2453
克隆号:GM305
-
![]() Fos-B 兔抗人 Fos-B蛋白 抗体试剂(免疫组织化学法)
Fos-B 兔抗人 Fos-B蛋白 抗体试剂(免疫组织化学法)
-
![]() 紧密连接蛋白-7(Claudin7)抗体 兔抗人 Claudin-7
Clone Name:EPR18073
紧密连接蛋白-7(Claudin7)抗体 兔抗人 Claudin-7
Clone Name:EPR18073
-
![]() CD138抗体试剂(免疫组织化学)
货号:GT2451
克隆号:GR106
CD138抗体试剂(免疫组织化学)
货号:GT2451
克隆号:GR106
-
![]() RUNX2抗体试剂(免疫组织化学法)
货号:GT2602
克隆号:GR025
RUNX2抗体试剂(免疫组织化学法)
货号:GT2602
克隆号:GR025
-
![]() c-Fos 兔抗人 c-Fos蛋白 抗体试剂(免疫组织化学法)
货号;GT2448
克隆号;GR027
c-Fos 兔抗人 c-Fos蛋白 抗体试剂(免疫组织化学法)
货号;GT2448
克隆号;GR027
-
![]() FH 鼠抗人 FH 抗体试剂(免疫组织化学法)
货号:GT2444
克隆号:J-13
FH 鼠抗人 FH 抗体试剂(免疫组织化学法)
货号:GT2444
克隆号:J-13
-
![]() I 型胶原(CollagenType I)抗体 兔抗人 CollagenType I
Clone Name:EP236
I 型胶原(CollagenType I)抗体 兔抗人 CollagenType I
Clone Name:EP236
-
![]() 细胞角蛋白7(CK7)抗体 鼠抗人 CK7
Clone Name:GM303
细胞角蛋白7(CK7)抗体 鼠抗人 CK7
Clone Name:GM303
-
![]() 细胞角蛋白5&6抗体试剂(免疫组织化学)
货号:GT2438
克隆号:RM341
细胞角蛋白5&6抗体试剂(免疫组织化学)
货号:GT2438
克隆号:RM341
-
![]() Uroplakin Ⅱ 鼠抗人 Uroplakin Ⅱ 抗体试剂(免疫组织化学法)
Uroplakin Ⅱ 鼠抗人 Uroplakin Ⅱ 抗体试剂(免疫组织化学法)
-
![]() 紧密连接蛋白-3(Claudin-3)抗体试剂(免疫组织化学法)
货号:GT2399
克隆号:GR124
紧密连接蛋白-3(Claudin-3)抗体试剂(免疫组织化学法)
货号:GT2399
克隆号:GR124
-
![]() Claudin18.2 兔抗人 细胞紧密连接蛋白18.2抗体试剂(免疫组织化学法)
货号:GT2441
克隆号:RM510
Claudin18.2 兔抗人 细胞紧密连接蛋白18.2抗体试剂(免疫组织化学法)
货号:GT2441
克隆号:RM510
-
![]() CD247
货号:GT2442
克隆号:GM105
CD247
货号:GT2442
克隆号:GM105
-
![]() H3K36M 兔抗人 H3K36M 抗体试剂(免疫组织化学法)
H3K36M 兔抗人 H3K36M 抗体试剂(免疫组织化学法)
-
![]() H3.3G34W 兔抗人 H3.3G34W 抗体试剂(免疫组织化学法)
H3.3G34W 兔抗人 H3.3G34W 抗体试剂(免疫组织化学法)
-
![]() 巨细胞病毒(Cytomegalovirus)抗体 鼠抗人 CMV
Clone Name:DDG9+CCH2
巨细胞病毒(Cytomegalovirus)抗体 鼠抗人 CMV
Clone Name:DDG9+CCH2
-
![]() IgD抗体试剂(免疫组织化学)
货号:GT2376
克隆号:GR328
IgD抗体试剂(免疫组织化学)
货号:GT2376
克隆号:GR328
-
![]() HSP70 兔抗人 热休克蛋白 70(HSP70)抗体试剂(免疫组织化学法)
HSP70 兔抗人 热休克蛋白 70(HSP70)抗体试剂(免疫组织化学法)
-
![]() GS 兔抗人 Glutamine Synthetase 抗体试剂(免疫组织化学)
GS 兔抗人 Glutamine Synthetase 抗体试剂(免疫组织化学)
-
![]() p16 抗体试剂 鼠抗人 p16
Clone Name:G175-405
p16 抗体试剂 鼠抗人 p16
Clone Name:G175-405
-
![]() C-erbB-2(Her-2/neu)兔抗人 C-erbB-2
Clone Name:SP3
C-erbB-2(Her-2/neu)兔抗人 C-erbB-2
Clone Name:SP3
-
![]() BRAF抗体试剂(免疫组织化学)
货号:GT2435
克隆号:RM8
BRAF抗体试剂(免疫组织化学)
货号:GT2435
克隆号:RM8
-
![]() CD103抗体试剂(免疫组织化学法)
货号:GT2430
克隆号:EP206
CD103抗体试剂(免疫组织化学法)
货号:GT2430
克隆号:EP206
-
![]() MASH1 兔抗人 MASH1 抗体试剂(免疫组织化学法)
MASH1 兔抗人 MASH1 抗体试剂(免疫组织化学法)
-
![]() IgG3 鼠抗人 IgG3 抗体试剂(免疫组织化学法)
IgG3 鼠抗人 IgG3 抗体试剂(免疫组织化学法)
-
![]() c-Maf 抗体 兔抗人 c-Maf
多克隆
c-Maf 抗体 兔抗人 c-Maf
多克隆
-
![]() Oct-4 兔抗人 Oct4 抗体试剂(免疫组织化学)
Oct-4 兔抗人 Oct4 抗体试剂(免疫组织化学)
-
![]() SSTR2 兔抗人 生长抑素受体2(SSTR2)抗体试剂(免疫组织化学法)
SSTR2 兔抗人 生长抑素受体2(SSTR2)抗体试剂(免疫组织化学法)
-
![]() Ksp-Cadherin 兔抗人 Ksp-Cadherin 抗体试剂(免疫组织化学)
Ksp-Cadherin 兔抗人 Ksp-Cadherin 抗体试剂(免疫组织化学)
-
![]() HIF-1α 兔抗人 HIF-1α 抗体试剂(免疫组织化学)
HIF-1α 兔抗人 HIF-1α 抗体试剂(免疫组织化学)
-
![]() TP 鼠抗人 胸苷磷酸化酶(TP)抗体试剂(免疫组织化学法)
Clone Name:P-GF.44C
TP 鼠抗人 胸苷磷酸化酶(TP)抗体试剂(免疫组织化学法)
Clone Name:P-GF.44C
-
![]() hCG-α 兔抗人 人糖蛋白激素α亚基(hCG-α)抗体试剂(免疫组织化学法)
hCG-α 兔抗人 人糖蛋白激素α亚基(hCG-α)抗体试剂(免疫组织化学法)
-
![]() PAX-2 兔抗人 Pax-2 抗体试剂(免疫组织化学)
PAX-2 兔抗人 Pax-2 抗体试剂(免疫组织化学)
-
![]() CD25抗体试剂(免疫组织化学)
货号:GT2364
克隆号:GR104
CD25抗体试剂(免疫组织化学)
货号:GT2364
克隆号:GR104
-
![]() FOXA1抗体试剂(免疫组织化学)
货号:GT2360
克隆号:EPR10881
FOXA1抗体试剂(免疫组织化学)
货号:GT2360
克隆号:EPR10881
-
![]() CD146抗体试剂(免疫组织化学法)
货号:GT2346
克隆号:EP54
CD146抗体试剂(免疫组织化学法)
货号:GT2346
克隆号:EP54
-
![]() 紧密连接蛋白-4(Claudin-4)抗体试剂(免疫组织化学法)
货号:GT2339
克隆号:GR123
紧密连接蛋白-4(Claudin-4)抗体试剂(免疫组织化学法)
货号:GT2339
克隆号:GR123
-
![]() NF Kappa B/p50 鼠抗人 NF Kappa B/p50 抗体试剂(免疫组织化学)
NF Kappa B/p50 鼠抗人 NF Kappa B/p50 抗体试剂(免疫组织化学)
-
![]() MRP3 兔抗人 MRP3 抗体试剂(免疫组织化学)
MRP3 兔抗人 MRP3 抗体试剂(免疫组织化学)
-
![]() SDHB 兔抗人 SDHB 抗体试剂(免疫组织化学)
SDHB 兔抗人 SDHB 抗体试剂(免疫组织化学)
-
![]() NKX2.2 兔抗人 NKX2.2 抗体试剂(免疫组织化学法)
NKX2.2 兔抗人 NKX2.2 抗体试剂(免疫组织化学法)
-
![]() TGF-β1 鼠抗人 TGF-β1 抗体试剂(免疫组织化学)
TGF-β1 鼠抗人 TGF-β1 抗体试剂(免疫组织化学)
-
![]() Rb Gene Protein抗体试剂(免疫组织化学)
货号:GT2342
克隆号:GR034
Rb Gene Protein抗体试剂(免疫组织化学)
货号:GT2342
克隆号:GR034
-
![]() 细胞角蛋白10 & 13(CK10 & 13)抗体 鼠抗人 CK10/13
Clone Name:DE-K13
细胞角蛋白10 & 13(CK10 & 13)抗体 鼠抗人 CK10/13
Clone Name:DE-K13
-
![]() T-Pit 鼠抗人 T-PIT 抗体试剂(免疫组织化学法)
T-Pit 鼠抗人 T-PIT 抗体试剂(免疫组织化学法)
-
![]() THSD7A 兔抗人 THSD7A 抗体试剂(免疫组织化学法)
货号:GT2587
克隆号:1F15-L1
THSD7A 兔抗人 THSD7A 抗体试剂(免疫组织化学法)
货号:GT2587
克隆号:1F15-L1
-
![]() SF-1 兔抗人 类固醇生成因子-1(SF-1)抗体试剂(免疫组织化学法)
SF-1 兔抗人 类固醇生成因子-1(SF-1)抗体试剂(免疫组织化学法)
-
![]() PNL2 鼠抗人 PNL2 抗体试剂(免疫组织化学法)
PNL2 鼠抗人 PNL2 抗体试剂(免疫组织化学法)
-
![]() PIT-1 兔抗人 生长激素因子-1(PIT-1)抗体试剂(免疫组织化学法)
PIT-1 兔抗人 生长激素因子-1(PIT-1)抗体试剂(免疫组织化学法)
-
![]() PDX1 兔抗人 PDX1
PDX1 兔抗人 PDX1
-
![]() p63 兔抗人 p63 抗体试剂(免疫组织化学)
p63 兔抗人 p63 抗体试剂(免疫组织化学)
-
![]() p40 兔抗人 p40 抗体试剂(免疫组织化学)
货号:GT2338
克隆号:GR006
p40 兔抗人 p40 抗体试剂(免疫组织化学)
货号:GT2338
克隆号:GR006
-
![]() Oct-2 兔抗人 Oct2 抗体试剂(免疫组织化学)
Oct-2 兔抗人 Oct2 抗体试剂(免疫组织化学)
-
![]() 微小染色体维持蛋白2(MCM2)抗体试剂 兔抗人MCM2
Clone Name:EP40
微小染色体维持蛋白2(MCM2)抗体试剂 兔抗人MCM2
Clone Name:EP40
-
![]() HNF1β 兔抗人 HNF1-Beta 抗体试剂(免疫组织化学)
HNF1β 兔抗人 HNF1-Beta 抗体试剂(免疫组织化学)
-
![]() HGAL 兔抗人 HGAL 抗体试剂(免疫组织化学法)
HGAL 兔抗人 HGAL 抗体试剂(免疫组织化学法)
-
![]() H3K27Me3 兔抗人 H3K27Me3 抗体试剂(免疫组织化学法)
货号:GT2368
克隆号:RM175
H3K27Me3 兔抗人 H3K27Me3 抗体试剂(免疫组织化学法)
货号:GT2368
克隆号:RM175
-
![]() H3K27M 兔抗人 H3K27M 抗体试剂(免疫组织化学法)
H3K27M 兔抗人 H3K27M 抗体试剂(免疫组织化学法)
-
![]() GATA2 兔抗人 GATA2
GATA2 兔抗人 GATA2
-
![]() Collagen Type IV 抗体 兔抗人 Collagen Type IV
Clone Name:GR102
Collagen Type IV 抗体 兔抗人 Collagen Type IV
Clone Name:GR102
-
![]() 细胞角蛋白(广谱)抗体试剂(免疫组织化学)
货号:GT2322
克隆号:GR314
细胞角蛋白(广谱)抗体试剂(免疫组织化学)
货号:GT2322
克隆号:GR314
-
![]() CD22抗体试剂(免疫组织化学)
货号:GT2324
克隆号:GR101
CD22抗体试剂(免疫组织化学)
货号:GT2324
克隆号:GR101
-
![]() CD147
货号:GT2334
克隆号:GM103
CD147
货号:GT2334
克隆号:GM103
-
![]() SMARCA4/Brg1抗体试剂(免疫组织化学)
货号:GT2333
克隆号:GR005
SMARCA4/Brg1抗体试剂(免疫组织化学)
货号:GT2333
克隆号:GR005
-
![]() Brachyury抗体试剂(免疫组织化学法)
货号:GT2332
克隆号:GR501
Brachyury抗体试剂(免疫组织化学法)
货号:GT2332
克隆号:GR501
-
![]() VHL 鼠抗人 VHL 抗体试剂(免疫组织化学)
VHL 鼠抗人 VHL 抗体试剂(免疫组织化学)
-
![]() TLE1 鼠抗人 TLE1 抗体试剂(免疫组织化学)
TLE1 鼠抗人 TLE1 抗体试剂(免疫组织化学)
-
![]() STAT6 兔抗人 STAT6 抗体试剂(免疫组织化学法)
STAT6 兔抗人 STAT6 抗体试剂(免疫组织化学法)
-
![]() S100P 鼠抗人 S100P 抗体试剂(免疫组织化学)
S100P 鼠抗人 S100P 抗体试剂(免疫组织化学)
-
![]() SATB2 兔抗人 SATB2 抗体试剂(免疫组织化学法)
SATB2 兔抗人 SATB2 抗体试剂(免疫组织化学法)
-
![]() P-glycoprotein 兔抗人 P糖蛋白(P-Glycoprotein)抗体试剂(免疫组织化学法)
P-glycoprotein 兔抗人 P糖蛋白(P-Glycoprotein)抗体试剂(免疫组织化学法)
-
![]() MSH2 兔抗人 MSH2 抗体试剂(免疫组织化学)
MSH2 兔抗人 MSH2 抗体试剂(免疫组织化学)
-
![]() 间皮素蛋白(Mesothelin)抗体试剂(免疫组织化学法)
货号:GT2291
克隆号:GR518
间皮素蛋白(Mesothelin)抗体试剂(免疫组织化学法)
货号:GT2291
克隆号:GR518
-
![]() LMO2 兔抗人 LMO2 抗体试剂(免疫组织化学)
LMO2 兔抗人 LMO2 抗体试剂(免疫组织化学)
-
![]() LEF-1 兔抗人 LEF-1 抗体试剂(免疫组织化学)
LEF-1 兔抗人 LEF-1 抗体试剂(免疫组织化学)
-
![]() Laminin 鼠抗人 Laminin 抗体试剂(免疫组织化学)
Laminin 鼠抗人 Laminin 抗体试剂(免疫组织化学)
-
![]() IgA 兔抗人 IgA 抗体试剂(免疫组织化学)
货号:GA0262
克隆号:GR310
IgA 兔抗人 IgA 抗体试剂(免疫组织化学)
货号:GA0262
克隆号:GR310
-
![]() GM-CSF
货号:GT2303
克隆号:8G5
GM-CSF
货号:GT2303
克隆号:8G5
-
![]() CEA 抗体 兔抗人 癌胚抗原
多克隆
CEA 抗体 兔抗人 癌胚抗原
多克隆
-
![]() CD45R 抗体 鼠抗人 CD45RB
Clone Name:PD7/26
CD45R 抗体 鼠抗人 CD45RB
Clone Name:PD7/26
-
![]() Beta-catenin抗体试剂(免疫组织化学)
货号:GT2119
克隆号:EP35
Beta-catenin抗体试剂(免疫组织化学)
货号:GT2119
克隆号:EP35
-
![]() Amyloid-β β淀粉样蛋白
货号:GT2299
克隆号:B-4
Amyloid-β β淀粉样蛋白
货号:GT2299
克隆号:B-4
-
![]() CD68抗体试剂(免疫组织化学)
货号:GM0814
克隆号:KP1
CD68抗体试剂(免疫组织化学)
货号:GM0814
克隆号:KP1
-
![]() CD14抗体试剂(免疫组织化学)
货号:GT2298
克隆号:EP128
CD14抗体试剂(免疫组织化学)
货号:GT2298
克隆号:EP128
-
![]() CD4抗体试剂(免疫组织化学)
货号:GT2191
克隆号:EP204
CD4抗体试剂(免疫组织化学)
货号:GT2191
克隆号:EP204
-
![]() PRL 鼠抗人 PRL 抗体试剂(免疫组织化学)
PRL 鼠抗人 PRL 抗体试剂(免疫组织化学)
-
![]() MUM1 兔抗人 MUM1 抗体试剂(免疫组织化学)
MUM1 兔抗人 MUM1 抗体试剂(免疫组织化学)
-
![]() Kappa链抗体试剂(免疫组织化学)
货号:GT2247
克隆号:GM508
Kappa链抗体试剂(免疫组织化学)
货号:GT2247
克隆号:GM508
-
![]() Adipophilin/ADRP 亲脂素
货号:GT2292
克隆号:B-6
Adipophilin/ADRP 亲脂素
货号:GT2292
克隆号:B-6
-
![]() MDM2 鼠抗人 MDM2 抗体试剂(免疫组织化学)
货号:GT2154
克隆号:SMP14
MDM2 鼠抗人 MDM2 抗体试剂(免疫组织化学)
货号:GT2154
克隆号:SMP14
-
![]() c-MYC 抗体 兔抗人 c-Myc
Clone Name: EP121
c-MYC 抗体 兔抗人 c-Myc
Clone Name: EP121
-
![]() PTH 鼠抗人 PTH 甲状旁腺素 抗体试剂(免疫组织化学)
PTH 鼠抗人 PTH 甲状旁腺素 抗体试剂(免疫组织化学)
-
![]() PAX-6 兔抗人PAX-6
PAX-6 兔抗人PAX-6
-
![]() SALL4 鼠抗人 SALL4 抗体试剂(免疫组织化学)
SALL4 鼠抗人 SALL4 抗体试剂(免疫组织化学)
-
![]() EZH2 兔抗人 EZH2 抗体试剂(免疫组织化学)
EZH2 兔抗人 EZH2 抗体试剂(免疫组织化学)
-
![]() CD7抗体试剂(免疫组织化学)
货号:GT2282
克隆号:EP132
CD7抗体试剂(免疫组织化学)
货号:GT2282
克隆号:EP132
-
![]() Serotonin 兔抗人 Serotonin 抗体试剂(免疫组织化学)
Serotonin 兔抗人 Serotonin 抗体试剂(免疫组织化学)
-
![]() S100 鼠抗人 S100 抗体试剂(免疫组织化学)
S100 鼠抗人 S100 抗体试剂(免疫组织化学)
-
![]() 紧密连接蛋白-1(Claudin-1)抗体 兔抗人 细胞紧密连接蛋白1(Claudin1)
多克隆
紧密连接蛋白-1(Claudin-1)抗体 兔抗人 细胞紧密连接蛋白1(Claudin1)
多克隆
-
![]() PD-1 鼠抗人 程序性死亡受体1(PD-1)抗体试剂(免疫组织化学法)
PD-1 鼠抗人 程序性死亡受体1(PD-1)抗体试剂(免疫组织化学法)
-
![]() MCM3 兔抗人 MCM3
MCM3 兔抗人 MCM3
-
![]() SP-B 鼠抗人 Surfactant Protein B 抗体试剂(免疫组织化学)
SP-B 鼠抗人 Surfactant Protein B 抗体试剂(免疫组织化学)
-
![]() CD205
货号:GT2276
克隆号:EP176
CD205
货号:GT2276
克隆号:EP176
-
![]() 4型黏蛋白(MUC-4)抗体试剂(免疫组织化学法)
货号:GT2275
克隆号:GR329
4型黏蛋白(MUC-4)抗体试剂(免疫组织化学法)
货号:GT2275
克隆号:GR329
-
![]() NKX3.1 兔抗人 NKX3.1 抗体试剂(免疫组织化学法)
NKX3.1 兔抗人 NKX3.1 抗体试剂(免疫组织化学法)
-
![]() PD-L1 兔抗人 PD-L1
货号:GT2280
克隆号:ZR3
PD-L1 兔抗人 PD-L1
货号:GT2280
克隆号:ZR3
-
![]() Hemoglobin A 血红蛋白A
货号:GT2273
克隆号:EP124
Hemoglobin A 血红蛋白A
货号:GT2273
克隆号:EP124
-
![]() CD16抗体试剂(免疫组织化学)
货号:GT2203
克隆号:EP364
CD16抗体试剂(免疫组织化学)
货号:GT2203
克隆号:EP364
-
Gt a Mo IgG/FITC 羊抗鼠 免疫显色试剂(荧光二抗) 货号:GF0261 克隆号:poly
-
C1q抗体试剂(免疫组织化学)(荧光抗体) 货号:GF0254 克隆号:poly
-
Lambda链抗体试剂(免疫组织化学)(荧光抗体) 货号:GF0207 克隆号:poly
-
Kappa链抗体试剂(免疫组织化学)(荧光抗体) 货号:GF0206 克隆号:poly
-
Gt a Rb IgG/FITC 羊抗兔 免疫显色试剂(荧光二抗) 货号:GF0205 克隆号:poly
-
IgA抗体试剂(免疫组织化学)(荧光抗体) 货号:GF0204 克隆号:poly
-
IgM抗体试剂(免疫组织化学)(荧光抗体) 货号:GF0203 克隆号:poly
-
IgG抗体试剂(免疫组织化学)(荧光抗体) 货号:GF0202 克隆号:poly
-
C3c抗体试剂(免疫组织化学)(荧光抗体) 货号:GF0201 克隆号:poly
-
C4c抗体试剂(免疫组织化学)(荧光抗体) 货号:GF0169 克隆号:poly
-
纤维蛋白原(Fibrinogen)抗体试剂(免疫组织化学法)(荧光抗体) 货号:GF0111 克隆号:poly
-
![]() FRα 鼠抗人 叶酸受体α(FRα)抗体试剂(免疫组织化学法)
FRα 鼠抗人 叶酸受体α(FRα)抗体试剂(免疫组织化学法)
-
![]() MMP-2 鼠抗人 基质金属蛋白酶 2
MMP-2 鼠抗人 基质金属蛋白酶 2
-
![]() N-Cadherin 鼠抗人 神经性钙黏附蛋白(N-Cadherin)抗体试剂(免疫组织化学法)
N-Cadherin 鼠抗人 神经性钙黏附蛋白(N-Cadherin)抗体试剂(免疫组织化学法)
-
![]() Myf-4 鼠抗人 Myf-4
Myf-4 鼠抗人 Myf-4
-
![]() CD33抗体试剂(免疫组织化学法)
货号:GT2271
克隆号:EPR24370-124
CD33抗体试剂(免疫组织化学法)
货号:GT2271
克隆号:EPR24370-124
-
![]() CD11c抗体试剂(免疫组织化学法)
货号:GT2270
克隆号:5D11
CD11c抗体试剂(免疫组织化学法)
货号:GT2270
克隆号:5D11
-
![]() Podoplanin抗体试剂(免疫组织化学)
货号:GM3619
克隆号:D2-40
Podoplanin抗体试剂(免疫组织化学)
货号:GM3619
克隆号:D2-40
-
![]() DOG1 兔抗人 DOG1 抗体试剂(免疫组织化学)
DOG1 兔抗人 DOG1 抗体试剂(免疫组织化学)
-
![]() EGFR 兔抗人 EGFR(表皮生长因子受体)抗体试剂(免疫组织化学)
EGFR 兔抗人 EGFR(表皮生长因子受体)抗体试剂(免疫组织化学)
-
![]() Ep-CAM抗体试剂(免疫组织化学)
货号:GM0804
克隆号:GM503
Ep-CAM抗体试剂(免疫组织化学)
货号:GM0804
克隆号:GM503
-
![]() EMA 鼠抗人 EMA 抗体试剂(免疫组织化学)
EMA 鼠抗人 EMA 抗体试剂(免疫组织化学)
-
![]() ER 兔抗人 雌激素受体 抗体试剂(免疫组织化学法)
Clone Name:SP1
ER 兔抗人 雌激素受体 抗体试剂(免疫组织化学法)
Clone Name:SP1
-
![]() ERCC1 兔抗人 ERCC1 抗体试剂(免疫组织化学)
ERCC1 兔抗人 ERCC1 抗体试剂(免疫组织化学)
-
![]() ERG 兔抗人 ERG 抗体试剂(免疫组织化学法)
ERG 兔抗人 ERG 抗体试剂(免疫组织化学法)
-
![]() MOC-31抗体试剂(免疫组织化学)
货号:GM3525
克隆号:MOC-31
MOC-31抗体试剂(免疫组织化学)
货号:GM3525
克隆号:MOC-31
-
![]() Factor VIII 鼠抗人 Factor VIII受体 抗体试剂(免疫组织化学)(Factor VIII-R)(Factor 8)
Factor VIII 鼠抗人 Factor VIII受体 抗体试剂(免疫组织化学)(Factor VIII-R)(Factor 8)
-
![]() Fascin 鼠抗人 Fascin 抗体试剂(免疫组织化学)
Fascin 鼠抗人 Fascin 抗体试剂(免疫组织化学)
-
![]() Fibronectin 鼠抗人 Fibronectin 抗体试剂(免疫组织化学)
Fibronectin 鼠抗人 Fibronectin 抗体试剂(免疫组织化学)
-
![]() FLI-1 鼠抗人 FLI-1 抗体试剂(免疫组织化学)
FLI-1 鼠抗人 FLI-1 抗体试剂(免疫组织化学)
-
![]() FSH 鼠抗人 FSH 抗体试剂(免疫组织化学)
FSH 鼠抗人 FSH 抗体试剂(免疫组织化学)
-
![]() FOXP1 兔抗人 FOXP1 抗体试剂(免疫组织化学)
FOXP1 兔抗人 FOXP1 抗体试剂(免疫组织化学)
-
![]() Glypican 3 鼠抗人 Glypican 3 抗体试剂(免疫组织化学)
Glypican 3 鼠抗人 Glypican 3 抗体试剂(免疫组织化学)
-
![]() GST-π 鼠抗人 GST-π 抗体试剂(免疫组织化学)
GST-π 鼠抗人 GST-π 抗体试剂(免疫组织化学)
-
![]() Gastrin 兔抗人 Gastrin 抗体试剂(免疫组织化学)
Gastrin 兔抗人 Gastrin 抗体试剂(免疫组织化学)
-
![]() GCDFP-15 鼠抗人 GCDFP-15 抗体试剂(免疫组织化学)
GCDFP-15 鼠抗人 GCDFP-15 抗体试剂(免疫组织化学)
-
![]() Growth Hormone (GH) 鼠抗人 Human Growth Hormone抗体试剂(免疫组织化学)
货号:GA0570
克隆号:GM318
Growth Hormone (GH) 鼠抗人 Human Growth Hormone抗体试剂(免疫组织化学)
货号:GA0570
克隆号:GM318
-
![]() Granzyme B 鼠抗人 Granzyme B 抗体试剂(免疫组织化学)
Granzyme B 鼠抗人 Granzyme B 抗体试剂(免疫组织化学)
-
![]() GFAP 鼠抗人 胶质纤维酸性蛋白(Glial Fibrillary Acidic Protein,GFAP)抗体试剂(免疫组织化学)
GFAP 鼠抗人 胶质纤维酸性蛋白(Glial Fibrillary Acidic Protein,GFAP)抗体试剂(免疫组织化学)
-
![]() GLUT-1抗体试剂(免疫组织化学)
货号:GT2181
克隆号:GM114
GLUT-1抗体试剂(免疫组织化学)
货号:GT2181
克隆号:GM114
-
![]() Glucagon 兔抗人 Glucagon 抗体试剂(免疫组织化学)
Glucagon 兔抗人 Glucagon 抗体试剂(免疫组织化学)
-
![]() GATA3 兔抗人 GATA3 抗体试剂(免疫组织化学)
GATA3 兔抗人 GATA3 抗体试剂(免疫组织化学)
-
![]() Galectin-3 鼠抗人 Galectin-3 抗体试剂(免疫组织化学)
Galectin-3 鼠抗人 Galectin-3 抗体试剂(免疫组织化学)
-
![]() HPV 鼠抗人 Papilloma Virus 抗体试剂(免疫组织化学)
HPV 鼠抗人 Papilloma Virus 抗体试剂(免疫组织化学)
-
![]() Hep Par-1 鼠抗人 Hepatocyte 抗体试剂(免疫组织化学)
Hep Par-1 鼠抗人 Hepatocyte 抗体试剂(免疫组织化学)
-
![]() HBcAg 鼠抗人 乙型肝炎病毒核心抗原(HBcAg)抗体试剂(免疫组织化学法)
HBcAg 鼠抗人 乙型肝炎病毒核心抗原(HBcAg)抗体试剂(免疫组织化学法)
-
![]() HP 兔抗人 Helicobacter phlori 抗体试剂(免疫组织化学)
HP 兔抗人 Helicobacter phlori 抗体试剂(免疫组织化学)
-
![]() Human Chorionic Gonadotropin抗体试剂(免疫组织化学)
货号:GA0231
克隆号:poly
Human Chorionic Gonadotropin抗体试剂(免疫组织化学)
货号:GA0231
克隆号:poly
-
![]() HPL 兔抗人 Human Placental Lactogen 抗体试剂(免疫组织化学)
货号:GT2205
克隆号:GR321
HPL 兔抗人 Human Placental Lactogen 抗体试剂(免疫组织化学)
货号:GT2205
克隆号:GR321
-
![]() Milk Fat Globule 1 鼠抗人 HMFG1(乳脂肪球膜蛋白1)
Clone Name:EDM45
Milk Fat Globule 1 鼠抗人 HMFG1(乳脂肪球膜蛋白1)
Clone Name:EDM45
-
![]() HBsAg 鼠抗人 乙型肝炎病毒表面抗原(HBsAg) 抗体试剂(免疫组织化学法)
HBsAg 鼠抗人 乙型肝炎病毒表面抗原(HBsAg) 抗体试剂(免疫组织化学法)
-
![]() IgM 兔抗人 IgM 抗体试剂(免疫组织化学)
IgM 兔抗人 IgM 抗体试剂(免疫组织化学)
-
![]() IgG抗体试剂(免疫组织化学)
货号:GA0423
克隆号:GR326
IgG抗体试剂(免疫组织化学)
货号:GA0423
克隆号:GR326
-
![]() Insulin 鼠抗人 Insulin 抗体试剂(免疫组织化学)
Insulin 鼠抗人 Insulin 抗体试剂(免疫组织化学)
-
![]() Inhibin α 兔抗人 Inhibin, alpha 抗体试剂(免疫组织化学)
Inhibin α 兔抗人 Inhibin, alpha 抗体试剂(免疫组织化学)
-
![]() IDH-1 鼠抗人 IDH-1 抗体试剂(免疫组织化学)
IDH-1 鼠抗人 IDH-1 抗体试剂(免疫组织化学)
-
![]() IgG4 兔抗人 IgG4 抗体试剂(免疫组织化学)
IgG4 兔抗人 IgG4 抗体试剂(免疫组织化学)
-
![]() INI-1 鼠抗人 INI-1 抗体试剂(免疫组织化学法)
INI-1 鼠抗人 INI-1 抗体试剂(免疫组织化学法)
-
![]() IMP3 兔抗人 IMP3 抗体试剂(免疫组织化学)
IMP3 兔抗人 IMP3 抗体试剂(免疫组织化学)
-
![]() Ki-67 兔抗人 Ki-67 抗体试剂(免疫组织化学)
Ki-67 兔抗人 Ki-67 抗体试剂(免疫组织化学)
-
![]() Ki-67 鼠抗人 Ki-67 抗体试剂(免疫组织化学)
Ki-67 鼠抗人 Ki-67 抗体试剂(免疫组织化学)
-
![]() Ki-67 鼠抗人 Ki-67 抗体试剂(免疫组织化学)
Ki-67 鼠抗人 Ki-67 抗体试剂(免疫组织化学)
-
![]() Lysozyme 兔抗人 Lysozyme 抗体试剂(免疫组织化学)
货号:GA0099
克隆号:GR308
Lysozyme 兔抗人 Lysozyme 抗体试剂(免疫组织化学)
货号:GA0099
克隆号:GR308
-
![]() LH 鼠抗人 Luteinizing Hormone 抗体试剂(免疫组织化学)
LH 鼠抗人 Luteinizing Hormone 抗体试剂(免疫组织化学)
-
![]() LRP 鼠抗人 LRP 抗体试剂(免疫组织化学)
LRP 鼠抗人 LRP 抗体试剂(免疫组织化学)
-
![]() Langerin抗体试剂(免疫组织化学)
货号:GT2090
克隆号:GR530
Langerin抗体试剂(免疫组织化学)
货号:GT2090
克隆号:GR530
-
![]() Lambda Light Chain 鼠抗人 Lambda链 抗体试剂(免疫组织化学)
Lambda Light Chain 鼠抗人 Lambda链 抗体试剂(免疫组织化学)
-
![]() EBV 鼠抗人 隐伏膜蛋白(EBV,LMP-1)抗体试剂(免疫组织化学法)
EBV 鼠抗人 隐伏膜蛋白(EBV,LMP-1)抗体试剂(免疫组织化学法)
-
![]() Smooth Muscle Myosin抗体试剂(免疫组织化学)
货号:GM3558
克隆号:GR317
Smooth Muscle Myosin抗体试剂(免疫组织化学)
货号:GM3558
克隆号:GR317
-
![]() Myoglobin 兔抗人 Myoglobin 抗体试剂(免疫组织化学)
货号:GT2031
克隆号:poly
Myoglobin 兔抗人 Myoglobin 抗体试剂(免疫组织化学)
货号:GT2031
克隆号:poly
-
![]() Myogenin 兔抗人 肌浆蛋白(Myogenin)抗体试剂(免疫组织化学法)
Myogenin 兔抗人 肌浆蛋白(Myogenin)抗体试剂(免疫组织化学法)
-
![]() MPO 兔抗人 Myeloperoxidase 抗体试剂(免疫组织化学)
MPO 兔抗人 Myeloperoxidase 抗体试剂(免疫组织化学)
-
![]() MBP 鼠抗人 Myelin Basic Protein 抗体试剂(免疫组织化学)
MBP 鼠抗人 Myelin Basic Protein 抗体试剂(免疫组织化学)
-
![]() MUC-5AC 鼠抗人 MUC5AC 抗体试剂(免疫组织化学)
MUC-5AC 鼠抗人 MUC5AC 抗体试剂(免疫组织化学)
-
![]() MUC-2 鼠抗人 MUC2 抗体试剂(免疫组织化学)
MUC-2 鼠抗人 MUC2 抗体试剂(免疫组织化学)
-
![]() MUC-1 鼠抗人 MUC-1 抗体试剂(免疫组织化学)
MUC-1 鼠抗人 MUC-1 抗体试剂(免疫组织化学)
-
![]() MMP-9 兔抗人 基质金属蛋白酶 9(MMP-9)抗体试剂(免疫组织化学法)
MMP-9 兔抗人 基质金属蛋白酶 9(MMP-9)抗体试剂(免疫组织化学法)
-
![]() MC 鼠抗人 MC 抗体试剂(免疫组织化学)
MC 鼠抗人 MC 抗体试剂(免疫组织化学)
-
![]() HMB-45 鼠抗人 HMB-45 抗体试剂(免疫组织化学)
HMB-45 鼠抗人 HMB-45 抗体试剂(免疫组织化学)
-
![]() MART-1/melan A抗体试剂 鼠抗人 Melan-A(黑色素A)
Clone Name:A103
MART-1/melan A抗体试剂 鼠抗人 Melan-A(黑色素A)
Clone Name:A103
-
![]() Mammaglobin 鼠抗人 Mammaglobin 抗体试剂(免疫组织化学)
Mammaglobin 鼠抗人 Mammaglobin 抗体试剂(免疫组织化学)
-
![]() Myo D1 兔抗人 Myo D1抗体试剂(免疫组织化学)
Myo D1 兔抗人 Myo D1抗体试剂(免疫组织化学)
-
![]() MLH1 鼠抗人 MLH1 抗体试剂(免疫组织化学)
MLH1 鼠抗人 MLH1 抗体试剂(免疫组织化学)
-
![]() MSH6 兔抗人 MSH6 抗体试剂(免疫组织化学)
MSH6 兔抗人 MSH6 抗体试剂(免疫组织化学)
-
![]() MUC6抗体试剂(免疫组织化学)
货号:GT2220
克隆号:GM329
MUC6抗体试剂(免疫组织化学)
货号:GT2220
克隆号:GM329
-
![]() MGMT 兔抗人 MGMT 抗体试剂(免疫组织化学法)
MGMT 兔抗人 MGMT 抗体试剂(免疫组织化学法)
-
![]() MCT 鼠抗人 MCT(肥大细胞胰蛋白酶)抗体试剂(免疫组织化学)
MCT 鼠抗人 MCT(肥大细胞胰蛋白酶)抗体试剂(免疫组织化学)
-
![]() Skeletal Myosin 鼠抗人 骨骼肌肌球蛋白(Skeletal Myosin)抗体试剂 (免疫组织化学法)
Skeletal Myosin 鼠抗人 骨骼肌肌球蛋白(Skeletal Myosin)抗体试剂 (免疫组织化学法)
-
![]() MiTF 鼠抗人 小眼相关转录因子(MiTF)抗体试剂(免疫组织化学法)
MiTF 鼠抗人 小眼相关转录因子(MiTF)抗体试剂(免疫组织化学法)
-
![]() MRP1 鼠抗人 多药耐药相关蛋白(MRP)抗体试剂(免疫组织化学法)
MRP1 鼠抗人 多药耐药相关蛋白(MRP)抗体试剂(免疫组织化学法)
-
![]() DSG3 鼠抗人 桥粒芯蛋白3(DSG3)抗体试剂(免疫组织化学法)
DSG3 鼠抗人 桥粒芯蛋白3(DSG3)抗体试剂(免疫组织化学法)
-
![]() Desmin 鼠抗人 Desmin抗体试剂(免疫组织化学)
Desmin 鼠抗人 Desmin抗体试剂(免疫组织化学)
-
![]() nm23 鼠抗人 nm23 抗体试剂(免疫组织化学)
nm23 鼠抗人 nm23 抗体试剂(免疫组织化学)
-
![]() NF 鼠抗人 Neurofilament 抗体试剂(免疫组织化学)
NF 鼠抗人 Neurofilament 抗体试剂(免疫组织化学)
-
![]() Napsin A抗体试剂(免疫组织化学)
货号:GT2185
克隆号:GM308
Napsin A抗体试剂(免疫组织化学)
货号:GT2185
克隆号:GM308
-
![]() NeuN 鼠抗人 NeuN 抗体试剂(免疫组织化学)
NeuN 鼠抗人 NeuN 抗体试剂(免疫组织化学)
-
![]() NSE抗体试剂(免疫组织化学)
货号:GT2196
克隆号:GR319
NSE抗体试剂(免疫组织化学)
货号:GT2196
克隆号:GR319
-
![]() Nestin 鼠抗人 Nestin 抗体试剂(免疫组织化学)
Nestin 鼠抗人 Nestin 抗体试剂(免疫组织化学)
-
![]() CA 125抗体试剂(免疫组织化学)
货号:GT2028
克隆号:GM115
CA 125抗体试剂(免疫组织化学)
货号:GT2028
克隆号:GM115
-
![]() NGFR 鼠抗人 NGFR 抗体试剂(免疫组织化学)
NGFR 鼠抗人 NGFR 抗体试剂(免疫组织化学)
-
![]() CA19-9抗体试剂(免疫组织化学)
货号:GT2120
克隆号:121SLE
CA19-9抗体试剂(免疫组织化学)
货号:GT2120
克隆号:121SLE
-
![]() E-Cadherin 兔抗人 E-Cadherin 抗体试剂(免疫组织化学)
货号:GT2107
克隆号:EP6
E-Cadherin 兔抗人 E-Cadherin 抗体试剂(免疫组织化学)
货号:GT2107
克隆号:EP6
-
![]() Oct-3/4 鼠抗人 Oct3/4 抗体试剂(免疫组织化学)
Oct-3/4 鼠抗人 Oct3/4 抗体试剂(免疫组织化学)
-
![]() Oligo-2 鼠抗人 Oligo-2 抗体试剂(免疫组织化学)
Oligo-2 鼠抗人 Oligo-2 抗体试剂(免疫组织化学)
-
![]() Calcitonin降钙素抗体试剂(免疫组织化学)
货号:GT2066
克隆号:GM304
Calcitonin降钙素抗体试剂(免疫组织化学)
货号:GT2066
克隆号:GM304
-
![]() PTEN 兔抗人 PTEN 抗体试剂(免疫组织化学法)
PTEN 兔抗人 PTEN 抗体试剂(免疫组织化学法)
-
![]() PS2 鼠抗人 pS2 抗体试剂(免疫组织化学)
PS2 鼠抗人 pS2 抗体试剂(免疫组织化学)
-
![]() Caldesmon抗体试剂(免疫组织化学)
货号:GM3557
克隆号:h-CALD
Caldesmon抗体试剂(免疫组织化学)
货号:GM3557
克隆号:h-CALD
-
![]() PSMA 鼠抗人 PSMA 抗体试剂(免疫组织化学)
货号:GT2051
克隆号:GM510
PSMA 鼠抗人 PSMA 抗体试剂(免疫组织化学)
货号:GT2051
克隆号:GM510
-
![]() PSAP抗体试剂(免疫组织化学)
货号:GT2039
克隆号:ZR443
PSAP抗体试剂(免疫组织化学)
货号:GT2039
克隆号:ZR443
-
![]() Calretinin抗体试剂(免疫组织化学)
货号:GT2009
克隆号:poly
Calretinin抗体试剂(免疫组织化学)
货号:GT2009
克隆号:poly
-
![]() PSA 鼠抗人 PSA 抗体试剂(免疫组织化学)
PSA 鼠抗人 PSA 抗体试剂(免疫组织化学)
-
![]() Calponin抗体试剂(免疫组织化学)
货号:GM3556
克隆号:CALP
Calponin抗体试剂(免疫组织化学)
货号:GM3556
克隆号:CALP
-
![]() PCNA 鼠抗人 PCNA 抗体试剂(免疫组织化学)
PCNA 鼠抗人 PCNA 抗体试剂(免疫组织化学)
-
![]() 组织蛋白酶D(CathepsinD)抗体试剂(免疫组织化学法)
货号:GT2033
克隆号:C5
组织蛋白酶D(CathepsinD)抗体试剂(免疫组织化学法)
货号:GT2033
克隆号:C5
-
![]() PR,Progesterone Receptor 鼠抗人 孕激素受体 (PR)
Clone Name:16
PR,Progesterone Receptor 鼠抗人 孕激素受体 (PR)
Clone Name:16
-
![]() PR 兔抗人 孕激素受体检测试剂盒(免疫组织化学法)
PR 兔抗人 孕激素受体检测试剂盒(免疫组织化学法)
-
![]() PMS2 抗体试剂(免疫组织化学)
货号:GT2159
克隆号:EP51
PMS2 抗体试剂(免疫组织化学)
货号:GT2159
克隆号:EP51
-
![]() PC 鼠抗人 PC 抗体试剂(免疫组织化学)
PC 鼠抗人 PC 抗体试剂(免疫组织化学)
-
![]() PLAP 鼠抗人 PLAP 抗体试剂(免疫组织化学)
PLAP 鼠抗人 PLAP 抗体试剂(免疫组织化学)
-
![]() Protein Gene Product 9.5抗体试剂(免疫组织化学)
货号:GZ5116
克隆号:GR512
Protein Gene Product 9.5抗体试剂(免疫组织化学)
货号:GZ5116
克隆号:GR512
-
![]() Perforin 鼠抗人 穿孔素(Perforin)抗体试剂(免疫组织化学法)
Perforin 鼠抗人 穿孔素(Perforin)抗体试剂(免疫组织化学法)
-
![]() Pax-8 兔抗人 Pax-8 抗体试剂(免疫组织化学)
Pax-8 兔抗人 Pax-8 抗体试剂(免疫组织化学)
-
![]() PAX-5 兔抗人 Pax-5 抗体试剂(免疫组织化学)
PAX-5 兔抗人 Pax-5 抗体试剂(免疫组织化学)
-
![]() AMACR/p504s抗体试剂(免疫组织化学)
货号:GT2001
克隆号:13H4
AMACR/p504s抗体试剂(免疫组织化学)
货号:GT2001
克隆号:13H4
-
![]() p120抗体试剂(免疫组织化学)
货号:GT2099
克隆号:EP66
p120抗体试剂(免疫组织化学)
货号:GT2099
克隆号:EP66
-
![]() p63 鼠抗人 p63 抗体试剂(免疫组织化学)
货号:GM7247
克隆号:4A4
p63 鼠抗人 p63 抗体试剂(免疫组织化学)
货号:GM7247
克隆号:4A4
-
![]() p57 鼠抗人 p57 抗体试剂(免疫组织化学)
p57 鼠抗人 p57 抗体试剂(免疫组织化学)
-
![]() p53 鼠抗人 p53 抗体试剂(免疫组织化学)(DO-7)
p53 鼠抗人 p53 抗体试剂(免疫组织化学)(DO-7)
-
![]() p53 鼠抗人 p53 抗体试剂(免疫组织化学)
p53 鼠抗人 p53 抗体试剂(免疫组织化学)
-
![]() p27 Kip1 鼠抗人 p27 抗体试剂(免疫组织化学)
p27 Kip1 鼠抗人 p27 抗体试剂(免疫组织化学)
-
![]() p21/WAF1抗体试剂(免疫组织化学)
货号:GT2043
克隆号:GR029
p21/WAF1抗体试剂(免疫组织化学)
货号:GT2043
克隆号:GR029
-
![]() p16 鼠抗人 p16 抗体试剂(免疫组织化学)
p16 鼠抗人 p16 抗体试剂(免疫组织化学)
-
![]() PHH3 兔抗人 磷酸化组蛋白H3(PHH3)抗体试剂(免疫组织化学法)
货号:GT2193
克隆号:ZR285
PHH3 兔抗人 磷酸化组蛋白H3(PHH3)抗体试剂(免疫组织化学法)
货号:GT2193
克隆号:ZR285
-
![]() CEA 抗体 鼠抗人 癌胚抗原
Clone Name:COL-1
CEA 抗体 鼠抗人 癌胚抗原
Clone Name:COL-1
-
![]() PI3K P85 兔抗人 PI3K P85
PI3K P85 兔抗人 PI3K P85
-
![]() CD1a抗体试剂(免疫组织化学)
货号:GM3571
克隆号:GR533
CD1a抗体试剂(免疫组织化学)
货号:GM3571
克隆号:GR533
-
![]() CD2抗体试剂(免疫组织化学)
货号:GM7309
克隆号:GR103
CD2抗体试剂(免疫组织化学)
货号:GM7309
克隆号:GR103
-
![]() CD3抗体试剂(免疫组织化学)
货号:GT2002
克隆号:LN10
CD3抗体试剂(免疫组织化学)
货号:GT2002
克隆号:LN10
-
![]() RCC 鼠抗人 Renal Cell Carcinoma Marker 抗体试剂(免疫组织化学)
RCC 鼠抗人 Renal Cell Carcinoma Marker 抗体试剂(免疫组织化学)
-
![]() RRM1 兔抗人 RRM1 抗体试剂(免疫组织化学)
RRM1 兔抗人 RRM1 抗体试剂(免疫组织化学)
-
![]() CD3抗体试剂(免疫组织化学)
货号:GA0452
克隆号:GR107
CD3抗体试剂(免疫组织化学)
货号:GA0452
克隆号:GR107
-
![]() Synaptophysin抗体试剂(免疫组织化学)
货号:GT2065
克隆号:SP11
Synaptophysin抗体试剂(免疫组织化学)
货号:GT2065
克隆号:SP11
-
![]() Survivin 兔抗人 存活素(Survivin)抗体试剂(免疫组织化学法)
Survivin 兔抗人 存活素(Survivin)抗体试剂(免疫组织化学法)
-
![]() CD5抗体试剂(免疫组织化学)
货号:GM3633
克隆号:GR526
CD5抗体试剂(免疫组织化学)
货号:GM3633
克隆号:GR526
-
![]() 肺表面活性蛋白A(Surfactant Protein A)抗体试剂(免疫组织化学法)
货号:GT2041
克隆号:GR333
肺表面活性蛋白A(Surfactant Protein A)抗体试剂(免疫组织化学法)
货号:GT2041
克隆号:GR333
-
![]() CD8 抗体 兔抗人 CD8
Clone Name:SP16
CD8 抗体 兔抗人 CD8
Clone Name:SP16
-
![]() CD10抗体试剂(免疫组织化学)
货号:GT2004
克隆号:GM106
CD10抗体试剂(免疫组织化学)
货号:GT2004
克隆号:GM106
-
![]() SOX-2 鼠抗人 SOX-2 抗体试剂(免疫组织化学)
SOX-2 鼠抗人 SOX-2 抗体试剂(免疫组织化学)
-
![]() CD15抗体试剂(免疫组织化学)
货号:GT2118
克隆号:MMA
CD15抗体试剂(免疫组织化学)
货号:GT2118
克隆号:MMA
-
![]() Somatostatin 鼠抗人 Somatostatin 抗体试剂(免疫组织化学)
Somatostatin 鼠抗人 Somatostatin 抗体试剂(免疫组织化学)
-
![]() Smoothelin抗体试剂(免疫组织化学法)
货号:GT2616
克隆号:4RA
Smoothelin抗体试剂(免疫组织化学法)
货号:GT2616
克隆号:4RA
-
![]() S100 兔抗人 S100 抗体试剂(免疫组织化学)
货号:GZ0311
克隆号:GR511
S100 兔抗人 S100 抗体试剂(免疫组织化学)
货号:GZ0311
克隆号:GR511
-
![]() SOX-11 兔抗人 SOX-11 抗体试剂(免疫组织化学)
SOX-11 兔抗人 SOX-11 抗体试剂(免疫组织化学)
-
![]() CD20cy 鼠抗人 CD20
Clone Name:L26
CD20cy 鼠抗人 CD20
Clone Name:L26
-
![]() CD19抗体试剂(免疫组织化学)
货号:GT2128
克隆号:GR105
CD19抗体试剂(免疫组织化学)
货号:GT2128
克隆号:GR105
-
![]() CD21抗体试剂(免疫组织化学)
货号:GT2097
克隆号:EP64
CD21抗体试剂(免疫组织化学)
货号:GT2097
克隆号:EP64
-
![]() Stathmin 兔抗人 微管解聚蛋白(Stathmin)抗体试剂(免疫组织化学法)
Stathmin 兔抗人 微管解聚蛋白(Stathmin)抗体试剂(免疫组织化学法)
-
![]() SOX-10 鼠抗人 SOX-10 抗体试剂(免疫组织化学法)
货号:GT2210
克隆号:GM005
SOX-10 鼠抗人 SOX-10 抗体试剂(免疫组织化学法)
货号:GT2210
克隆号:GM005
-
![]() CD23抗体试剂(免疫组织化学)
货号:GT2098
克隆号:EP75
CD23抗体试剂(免疫组织化学)
货号:GT2098
克隆号:EP75
-
![]() Tyrosinase 鼠抗人 Tyrosinase 抗体试剂(免疫组织化学)
Tyrosinase 鼠抗人 Tyrosinase 抗体试剂(免疫组织化学)
-
![]() CD30抗体试剂(免疫组织化学)
货号:GT2139
克隆号:JCM182
CD30抗体试剂(免疫组织化学)
货号:GT2139
克隆号:JCM182
-
![]() Tubulin β-III 鼠抗人 β-tubulin-III 抗体试剂(免疫组织化学)
Tubulin β-III 鼠抗人 β-tubulin-III 抗体试剂(免疫组织化学)
-
![]() TPO 兔抗人TPO 抗体试剂(免疫组织化学)
TPO 兔抗人TPO 抗体试剂(免疫组织化学)
-
![]() TOP2A抗体试剂(免疫组织化学)
货号:GM7186
克隆号;GR003
TOP2A抗体试剂(免疫组织化学)
货号:GM7186
克隆号;GR003
-
![]() CD31抗体试剂(免疫组织化学)
货号:GT2321
克隆号:GM100
CD31抗体试剂(免疫组织化学)
货号:GT2321
克隆号:GM100
-
![]() CD34抗体试剂(免疫组织化学)
货号:GM7165
克隆号:QBEnd 10
CD34抗体试剂(免疫组织化学)
货号:GM7165
克隆号:QBEnd 10
-
![]() TIA-1 鼠抗人 TIA-1 抗体试剂(免疫组织化学)
TIA-1 鼠抗人 TIA-1 抗体试剂(免疫组织化学)
-
![]() CD35抗体试剂(免疫组织化学)
货号:GT2307
克隆号:EP197
CD35抗体试剂(免疫组织化学)
货号:GT2307
克隆号:EP197
-
![]() 甲状腺转录因子-1(TTF-1)抗体试剂(免疫组织化学)
货号:GT2180
克隆号:SPT24
甲状腺转录因子-1(TTF-1)抗体试剂(免疫组织化学)
货号:GT2180
克隆号:SPT24
-
![]() CD38抗体试剂(免疫组织化学)
货号:GT2129
克隆号:SPC32
CD38抗体试剂(免疫组织化学)
货号:GT2129
克隆号:SPC32
-
![]() TSH 鼠抗人 Thyroid Stimulating Hormone 抗体试剂(免疫组织化学)
TSH 鼠抗人 Thyroid Stimulating Hormone 抗体试剂(免疫组织化学)
-
![]() THY抗体试剂(免疫组织化学法)(TG)
货号:GT2122
克隆号:2H11/6E1
THY抗体试剂(免疫组织化学法)(TG)
货号:GT2122
克隆号:2H11/6E1
-
![]() CD43抗体试剂(免疫组织化学)
货号:GM0786
克隆号:DF-T1
CD43抗体试剂(免疫组织化学)
货号:GM0786
克隆号:DF-T1
-
![]() TS 鼠抗人 胸苷酸合成酶(Thymidylate Synthase,TS)抗体试剂(免疫组织化学法)
货号:GM3614
克隆号:GM509
TS 鼠抗人 胸苷酸合成酶(Thymidylate Synthase,TS)抗体试剂(免疫组织化学法)
货号:GM3614
克隆号:GM509
-
![]() CD44抗体试剂(免疫组织化学)
货号:GM7082
克隆号:DF1485
CD44抗体试剂(免疫组织化学)
货号:GM7082
克隆号:DF1485
-
![]() TFE3 兔抗人 TFE3 抗体试剂(免疫组织化学)
TFE3 兔抗人 TFE3 抗体试剂(免疫组织化学)
-
![]() CD44v6抗体试剂(免疫组织化学法)
货号:GT2020
克隆号:GM110
CD44v6抗体试剂(免疫组织化学法)
货号:GT2020
克隆号:GM110
-
![]() CD45抗体试剂(免疫组织化学)
货号:GM0701
克隆号:2B11+PD7/26/16
CD45抗体试剂(免疫组织化学)
货号:GM0701
克隆号:2B11+PD7/26/16
-
![]() CD45R抗体试剂(免疫组织化学)
货号:GM0754
克隆号:4KB
CD45R抗体试剂(免疫组织化学)
货号:GM0754
克隆号:4KB
-
![]() CD45RO抗体试剂(免疫组织化学)
货号:GM0742
克隆号:UCHL1
CD45RO抗体试剂(免疫组织化学)
货号:GM0742
克隆号:UCHL1
-
![]() CD56抗体试剂(免疫组织化学)
货号:GT2005
克隆号:123C3
CD56抗体试剂(免疫组织化学)
货号:GT2005
克隆号:123C3
-
![]() CD57抗体试剂(免疫组织化学)
货号:GT2011
克隆号:NK-1
CD57抗体试剂(免疫组织化学)
货号:GT2011
克隆号:NK-1
-
![]() CD61抗体试剂(免疫组织化学)
货号:GT2141
克隆号:2f2
CD61抗体试剂(免疫组织化学)
货号:GT2141
克隆号:2f2
-
![]() CD63抗体试剂(免疫组织化学)
货号:GT2142
克隆号:NKI/C3
CD63抗体试剂(免疫组织化学)
货号:GT2142
克隆号:NKI/C3
-
![]() CD71 抗体 鼠抗人 CD71
Clone Name:10F11
CD71 抗体 鼠抗人 CD71
Clone Name:10F11
-
![]() CD74 抗体试剂 鼠抗人 CD74
Clone Name:LN2
CD74 抗体试剂 鼠抗人 CD74
Clone Name:LN2
-
![]() CD79a 抗体 鼠抗人 CD79a
Clone Name:GM101
CD79a 抗体 鼠抗人 CD79a
Clone Name:GM101
-
![]() CD99 兔抗人 CD99 抗体试剂(免疫组织化学)
货号:GT2123
克隆号:EP8
CD99 兔抗人 CD99 抗体试剂(免疫组织化学)
货号:GT2123
克隆号:EP8
-
![]() CD105抗体试剂(免疫组织化学法)
货号:GT2328
克隆号:GM102
CD105抗体试剂(免疫组织化学法)
货号:GT2328
克隆号:GM102
-
![]() CD117(c-kit)兔抗人 CD117(c-kit)
货号:GA4502
克隆号:poly
CD117(c-kit)兔抗人 CD117(c-kit)
货号:GA4502
克隆号:poly
-
![]() CD123抗体试剂(免疫组织化学)
货号:GT2136
克隆号:BR4MS
CD123抗体试剂(免疫组织化学)
货号:GT2136
克隆号:BR4MS
-
![]() CD163抗体试剂(免疫组织化学)
货号:GT2077
克隆号:10D6
CD163抗体试剂(免疫组织化学)
货号:GT2077
克隆号:10D6
-
![]() CDX-2 抗体 兔抗人 CDX2
Clone Name:EP25
CDX-2 抗体 兔抗人 CDX2
Clone Name:EP25
-
![]() Chromogranin A(CgA)鼠抗人 Chromogranin 抗体试剂(免疫组织化学)
货号:GT2114
克隆号:GM306
Chromogranin A(CgA)鼠抗人 Chromogranin 抗体试剂(免疫组织化学)
货号:GT2114
克隆号:GM306
-
![]() COX-2 抗体 兔抗人 COX2
Clone Name:SP21
COX-2 抗体 兔抗人 COX2
Clone Name:SP21
-
![]() 细胞周期蛋白 D1 抗体 兔抗人 Cyclin D1
Clone Name:GR010
细胞周期蛋白 D1 抗体 兔抗人 Cyclin D1
Clone Name:GR010
-
![]() 细胞角蛋白(广谱)抗体 鼠抗人 CK,Pan(AE1/AE3)
Clone Name:AE1/3
细胞角蛋白(广谱)抗体 鼠抗人 CK,Pan(AE1/AE3)
Clone Name:AE1/3
-
![]() 细胞角蛋白CAM5.2抗体试剂(免疫组织化学)
货号:GT2091
克隆号:CAM5.2
细胞角蛋白CAM5.2抗体试剂(免疫组织化学)
货号:GT2091
克隆号:CAM5.2
-
![]() 细胞角蛋白 5(CK5)抗体 兔抗人 CK5
Clone Name:GR301
细胞角蛋白 5(CK5)抗体 兔抗人 CK5
Clone Name:GR301
-
![]() 细胞角蛋白5&6抗体试剂(免疫组织化学)
货号:GM7237
克隆号:EP24&EP67
细胞角蛋白5&6抗体试剂(免疫组织化学)
货号:GM7237
克隆号:EP24&EP67
-
![]() 细胞角蛋白7抗体试剂(免疫组织化学)
货号:GM7018
克隆号:OV-TL 12/30
细胞角蛋白7抗体试剂(免疫组织化学)
货号:GM7018
克隆号:OV-TL 12/30
-
![]() 细胞角蛋白 8 抗体 鼠抗人 CK8
Clone Name:TS1
细胞角蛋白 8 抗体 鼠抗人 CK8
Clone Name:TS1
-
![]() 细胞角蛋白8&18抗体试剂(免疫组织化学)
货号:GT2078
克隆号:GR330
细胞角蛋白8&18抗体试剂(免疫组织化学)
货号:GT2078
克隆号:GR330
-
![]() 细胞角蛋白10 抗体 鼠抗人 CK10
Clone Name:DE-K10
细胞角蛋白10 抗体 鼠抗人 CK10
Clone Name:DE-K10
-
![]() 细胞角蛋白 14 抗体 鼠抗人 CK14
Clone Name:LL002
细胞角蛋白 14 抗体 鼠抗人 CK14
Clone Name:LL002
-
![]() 细胞角蛋白 17 抗体 兔抗人 CK17
Clone Name:EP98
细胞角蛋白 17 抗体 兔抗人 CK17
Clone Name:EP98
-
![]() 细胞角蛋白 18 抗体 鼠抗人 CK18
Clone Name:DC-10
细胞角蛋白 18 抗体 鼠抗人 CK18
Clone Name:DC-10
-
![]() 细胞角蛋白 19 抗体 鼠抗人 CK19
Clone Name:RCK108
细胞角蛋白 19 抗体 鼠抗人 CK19
Clone Name:RCK108
-
![]() 细胞角蛋白 20 抗体 鼠抗人 CK20
Clone Name:KS20.8
细胞角蛋白 20 抗体 鼠抗人 CK20
Clone Name:KS20.8
-
![]() 细胞角蛋白(高分子量)抗体 鼠抗人 CK,HMW(34ßE12)
Clone Name:34βE12
细胞角蛋白(高分子量)抗体 鼠抗人 CK,HMW(34ßE12)
Clone Name:34βE12
-
![]() CK 鼠抗人 细胞角蛋白(AE1) 抗体试剂(免疫组织化学法)
货号:GT2079
克隆号:AE1
CK 鼠抗人 细胞角蛋白(AE1) 抗体试剂(免疫组织化学法)
货号:GT2079
克隆号:AE1
-
![]() GlycophorinA抗体试剂(免疫组织化学)
货号:GT2202
克隆号:JC159
GlycophorinA抗体试剂(免疫组织化学)
货号:GT2202
克隆号:JC159
-
![]() 钙黏附蛋白17(Cadherin17)抗体 鼠抗人 CDH17
Clone Name:SDM4
钙黏附蛋白17(Cadherin17)抗体 鼠抗人 CDH17
Clone Name:SDM4
-
![]() CD13抗体试剂(免疫组织化学)
货号:GT2218
克隆号:EP117
CD13抗体试剂(免疫组织化学)
货号:GT2218
克隆号:EP117
-
![]() CAIX碳酸酐酶9抗体试剂(免疫组织化学)
货号:GT2240
克隆号:H-11
CAIX碳酸酐酶9抗体试剂(免疫组织化学)
货号:GT2240
克隆号:H-11
-
![]() TdT 鼠抗人 TdT 抗体试剂(免疫组织化学)
货号:GT2025
克隆号:SEN28
TdT 鼠抗人 TdT 抗体试剂(免疫组织化学)
货号:GT2025
克隆号:SEN28
-
![]() TAU 兔抗人 TAU
多克隆
TAU 兔抗人 TAU
多克隆
-
![]() CK16 兔抗人 细胞角蛋白16(CK16)抗体试剂(免疫组织化学法)
货号:GT2228
克隆号:GR311
CK16 兔抗人 细胞角蛋白16(CK16)抗体试剂(免疫组织化学法)
货号:GT2228
克隆号:GR311
-
![]() Cyclin E 鼠抗人 细胞周期蛋白 E 抗体试剂(免疫组织化学)
货号:GT2231
克隆号:ZM121
Cyclin E 鼠抗人 细胞周期蛋白 E 抗体试剂(免疫组织化学)
货号:GT2231
克隆号:ZM121
-
![]() 细胞周期蛋白依赖性激酶4(CDK4)抗体 兔抗人 CDK4
Clone Name:EP180
细胞周期蛋白依赖性激酶4(CDK4)抗体 兔抗人 CDK4
Clone Name:EP180
-
![]() C-erbB-2 兔抗人 C-erbB-2(Her-2/neu)
Clone Name:EP3
C-erbB-2 兔抗人 C-erbB-2(Her-2/neu)
Clone Name:EP3
-
![]() CD54 鼠抗人 CD54
Clone Name:23G12
CD54 鼠抗人 CD54
Clone Name:23G12
-
![]() CD42b抗体试剂(免疫组织化学法)
货号:GT2238
克隆号:42C01
CD42b抗体试剂(免疫组织化学法)
货号:GT2238
克隆号:42C01
-
![]() CD117(c-kit)兔抗人 CD117(c-kit)
货号:GT2248
克隆号:YR145
CD117(c-kit)兔抗人 CD117(c-kit)
货号:GT2248
克隆号:YR145
-
![]() BCA-225抗体试剂(免疫组织化学)
货号:GT2134
克隆号;Cu-18
BCA-225抗体试剂(免疫组织化学)
货号:GT2134
克隆号;Cu-18
-
![]() bcl-6抗体试剂(免疫组织化学)
货号:GT2055
克隆号:GR024
bcl-6抗体试剂(免疫组织化学)
货号:GT2055
克隆号:GR024
-
![]() B淋巴细胞特异性激活OCT结合蛋白1(Bob.1)抗体试剂(免疫组织化学法)
货号:GT2284
克隆号:Wue-AC5
B淋巴细胞特异性激活OCT结合蛋白1(Bob.1)抗体试剂(免疫组织化学法)
货号:GT2284
克隆号:Wue-AC5
-
![]() Bak 兔抗人 Bak
多克隆
Bak 兔抗人 Bak
多克隆
-
![]() bcl-2抗体试剂(免疫组织化学)
货号:GM0887
克隆号:GR324
bcl-2抗体试剂(免疫组织化学)
货号:GM0887
克隆号:GR324
-
![]() Bax 抗体 鼠抗人 Bax
Clone Name:2D2
Bax 抗体 鼠抗人 Bax
Clone Name:2D2
-
![]() TAG-72抗体试剂(免疫组织化学)
货号:GT2076
克隆号:B72.3
TAG-72抗体试剂(免疫组织化学)
货号:GT2076
克隆号:B72.3
-
![]() TIMP-1 鼠抗人 TIMP-1
TIMP-1 鼠抗人 TIMP-1
-
![]() TIMP-2 鼠抗人 TIMP-2
TIMP-2 鼠抗人 TIMP-2
-
![]() TCL1 兔抗人 TCL1 抗体试剂(免疫组织化学)
TCL1 兔抗人 TCL1 抗体试剂(免疫组织化学)
-
![]() Uroplakin Ⅲ 兔抗人 Uroplakin Ⅲ 抗体试剂(免疫组织化学法)
Uroplakin Ⅲ 兔抗人 Uroplakin Ⅲ 抗体试剂(免疫组织化学法)
-
![]() Ubiquitin 鼠抗人 泛素
多克隆
Ubiquitin 鼠抗人 泛素
多克隆
-
![]() Vimentin 鼠抗人 Vimentin 抗体试剂(免疫组织化学)
Vimentin 鼠抗人 Vimentin 抗体试剂(免疫组织化学)
-
![]() Villin 兔抗人 Villin(微管素)抗体试剂(免疫组织化学)
Villin 兔抗人 Villin(微管素)抗体试剂(免疫组织化学)
-
![]() VEGF抗体试剂(免疫组织化学)
货号:GT2170
克隆号:GM328
VEGF抗体试剂(免疫组织化学)
货号:GT2170
克隆号:GM328
-
![]() WT1抗体试剂(免疫组织化学)
货号:GM3561
克隆号:6F-H2
WT1抗体试剂(免疫组织化学)
货号:GM3561
克隆号:6F-H2
-
![]() ZAP-70抗体试剂(免疫组织化学)
货号:GT2053
克隆号:GR334
ZAP-70抗体试剂(免疫组织化学)
货号:GT2053
克隆号:GR334
-
![]() AAT抗体试剂(免疫组织化学)
货号:GT2061
克隆号:poly
AAT抗体试剂(免疫组织化学)
货号:GT2061
克隆号:poly
-
![]() AACT抗体试剂(免疫组织化学)
货号:GT2062
克隆号:GR304
AACT抗体试剂(免疫组织化学)
货号:GT2062
克隆号:GR304
-
![]() Alpha-1-Fetoprotein抗体试剂(免疫组织化学)
货号:GA0008
克隆号:poly
Alpha-1-Fetoprotein抗体试剂(免疫组织化学)
货号:GA0008
克隆号:poly
-
![]() Actin抗体试剂(免疫组织化学)
货号:GM0635
克隆号:HHF35
Actin抗体试剂(免疫组织化学)
货号:GM0635
克隆号:HHF35
-
![]() ACTH抗体试剂(免疫组织化学)
货号:GT2127
克隆号:AH26
ACTH抗体试剂(免疫组织化学)
货号:GT2127
克隆号:AH26
-
![]() SMA 鼠抗人 SMA 抗体试剂(免疫组织化学)
SMA 鼠抗人 SMA 抗体试剂(免疫组织化学)
-
![]() 精氨酸酶1(Arginase-1)抗体试剂(免疫组织化学法)
货号:GT2183
克隆号:EP261
精氨酸酶1(Arginase-1)抗体试剂(免疫组织化学法)
货号:GT2183
克隆号:EP261
-
![]() 雄激素受体(Androgen Receptor,AR)抗体试剂(免疫组织化学法)
货号:GM3562
克隆号:EP120
雄激素受体(Androgen Receptor,AR)抗体试剂(免疫组织化学法)
货号:GM3562
克隆号:EP120
-
![]() ALDH1A1
货号:GT2216
克隆号:44
ALDH1A1
货号:GT2216
克隆号:44
-
![]() ATRX抗体试剂(免疫组织化学)
货号:GT2241
克隆号:D-5
ATRX抗体试剂(免疫组织化学)
货号:GT2241
克隆号:D-5
-
![]() ALK抗体试剂(免疫组织化学)
货号:GT2266
克隆号:4A4
ALK抗体试剂(免疫组织化学)
货号:GT2266
克隆号:4A4
-
![]() ALK抗体试剂(免疫组织化学)
货号:GT2311
克隆号:1H7
ALK抗体试剂(免疫组织化学)
货号:GT2311
克隆号:1H7